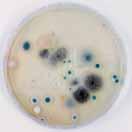

ПОСЛЕДНА ГЕНЕРАЦИЯ ИНТЕЛИГЕНТЕН ХИГИЕНЕН И МИКРОБИОЛОГИЧЕН КОНТРОЛ Посетете ни на специализираната изложба „СВЕТЪТ НА МЛЯКОТО” от 05 до 08 октомври, Интер Експо Център - София, зала 2, щанд В4 БИОКОМ ТРЕНДАФИЛОВ ЕООД, Сливен 8800, бул. "Стефан Караджа" 38А, телефон: +359 44 624 777; мобилен: +359 885 248 371; e-mail: sales@biokom-trend.com www.biokom-trend.com ПРОБА ОТ ВЪЗДУХ В ПОМЕЩЕНИЕ ПРЕДИ ДЕЗИНФЕКЦИЯ С ПРОБА ОТ ВЪЗДУХ В ПОМЕЩЕНИЕ СЛЕД ДЕЗИНФЕКЦИЯ С ИНОВАТИВНА СИСТЕМА ЗА ЕДНОВРЕМЕННА ДЕЗИНФЕКЦИЯ НА ВЪЗДУХ, ПОВЪРХНОСТИ И ОБОРУДВАНЕ МИКРОБИОЛОГИЧЕН КОНТРОЛ за 6-8 часа ХИГИЕНЕН КОНТРОЛ за 10 секунди Контрол на алергените
хляба като своя мисия 18


Генно-редактирани домати – нов източник на витамин Д 20 Интелигентно и устойчиво – могат ли опаковките да бъдат и двете? 22

Недостиг на меласа и поскъпваща енергия –
предизвикателство за производителите на мая 24
Полша увеличава износа на храни 25 Последната версия бутилка от влакна на Carlsberg 26

Вести от УХТ 29 Антиоксидантна активност на пиво тип ейл с добавени амарант и ядливи цветя 30 Електролиза на водата – възможности за приложение в хранително-вкусовата промишленост
Фирми, представени в броя: Агрифлекс АРСТ


Биоком Трендафилов ГОТИ

Д-р Грозева - Аромса Интер Експо Център Лесафре България Международен Пловдивски панаир Омега К Орион Матеев Приз Пак Сан Макс Трейд ТЕА Трейдинг Технокон Флоукрет ФНТС ЦСБ Систем България

Съдържание С ъ д ъ р ж а н и е
LXXI
6/2022
Година
Брой
Необходима е стратегия за месната индустрия у нас 5 Новости 8, 28, 42 Повишеното съдържание на метилживак
в рибите –сериозен риск за човешкото здраве 10 Аквакултурите и хранителната система на бъдещето 14 В Лесафр България приемаме
Част 1. Приложение на алкална електролизна вода 37 Бизнессправочник 43 20 Companies represented in the issue: Agriflex ARST Biocom Trendafilov GOTHI D-r Grozeva Aromsa Inter Expo Center International Plovdiv Fair Lesaffre Bulgaria Omega K Orion Mateev Priz Pack SanMax Trade TEA Trading Technocon Flowcrete FSEU CSB-System Bulgaria 10
Разбирате, че финансовата криза не ни е подминала и нас, още повече, че ние сме функция от Вас. Вярваме, че това няма да притесни нашите читатели и всички Вие ще продължите да бъдете с нас с помощта на вездесъщия Интернет. Списанието ще продължи да присъства в списъците на НАЦИД , което е важно за читателите ни, занимаващи се с хранителна наука, а за всички останали то се ангажира да бъде още по полезно с богата инфор мация за развитието на отрасъла у нас и по света. Приз Пак 2022 – Националният конкурс за най добра опа ковка вече е достатъчно популярен сред българските произво дители на опаковки и опаковъчни материали, а също на храни и напитки Очакваме Вашите заявки за участие в Конкурса и в съ пътстващата Научно практическа конференция на тема: „Тенденции в опаковането на храни и напитки – безопасност, качество, екология и нормативна уредба“, която ще бъде на 26 октомври. Повече информация на сайта ни




Здравейте, уважаеми читателю, Отиде си лятото и пак, както се казва, „Наесен с песен“… Едва ли на повечето от нас ни е до песен, но въпреки всичко животът си върви и трябва да се съобразяваме с неговите предизвикателства в гло бален план А в това объркано време те с всеки изминал ден се множат Няма да ги коментирам Просто трябва да намерим сили и някак си заедно (което се оказа много трудно за българите, въпреки девиза на държавата ни) да намерим правилните решения, за да устоим на връхлитащите ни кризи и да продължим напред. Но да се върнем в ежедневието си и предстоящите събития. Пловдив ни очаква с Техническия панаир от 19-и септември, а от 5-и октомври отварят врати групата хранителни изложение в Ин тер Експо Център София. Списание ХВП ще участва и в двете, така че там ще може да се видим, да поговорим и да ви предложим специализирана литература и абонамент за списанието. И понеже стана дума за абонамента искам да Ви информирам, че от новата 2023 година сп ХВП ще излиза само електрон
www fpim-bg.org Очакваме да се включите и в двете събития, за да докажем заедно, че умеем да се справяме с проблемите и има какво да покажем. За екипа на сп. ХВП Петко Делибеев, главен редактор Списание ХВП очаква Вашия абонамент. Изпратете ни e-mail адрес за получаване на списанието, името на получателя и данни за фактура на info@fpim-bg.org. Въпреки финансовата криза, цената на годишния абонамент остава 77,00 лв.
но
A strategy is needed for the meat industry in our country 5 News 8, 28, 42
The increased content of methylmercury in fish is a serious risk to human health 10
Aquacultures and the future food system 14
At Lesafr Bulgaria, we accept bread as our mission 18
Gene-edited tomatoes could be a new source of vitamin D 20
Smart and sustainable: Can packaging be both? 22
A shortage of molasses and rising energy costs –a challenge for yeast producers 24

Increase in the export of food from Poland 25 Carlsberg’s latest version fiber bottle 26


News from UFT 29
Antioxydant activity of ale type beer with added amaranth and eadible flowers 30
Electrolysis of water – possible applications in the food industry Part 1. Application of alkaline electrolyzed water 37 Businessguide 43
Печатно: ISSN 1311-0179 Онлайн: ISSN 2815-3723 Национално научно-приложно списание Издава КООП „ХВП” © Със съдействието на Университет по хранителни технологии Пловдив и Селскостопанска академия към МЗ Редколегия: проф. д-р Веселка Дулева дм, доц. Валентина Багдасарян, доц. Георги Джатов, проф. Йордан Гогов, Жана Величкова, доц. д.н. инж. Кирил Михалев, д-р инж. Магдалина Гаджева, Петко Делибеев, д-р Светлана Минкова, чл. кор. проф. д.т.н. инж. Стефан Драгоев, проф. Чавдар Дамянов Гл. редактор: Петко Делибеев, тел.: 02 988 05 89; e-mail: info@fpim-bg.org Маркетинг и реклама: Виолета Георгиева тел.: 02 988 05 89; e-mail: fpim_adv@abv.bg Дизайн: Зора Янчева, тел.: 02 988 05 89; е-mail: dizart@abv.bg Адрес на редакцията: София 1000, ул. „Раковски” 108, ет. 6, офис 605; GSM: 088 4646 919; Печат: Вуду принт ООД; www.voo-doo.eu Препечатването е разрешено с позоваване на източника. Редакцията не носи отговорност за съдържанието на рекламните и PR материали. Мнението на редакцията не винаги съвпада с мнението на авторите
Списание ХВП е включено в Списъка реферирани и индексирани издания на НАЦИД
FOOD PROCESSING INDUSTRY MAGAZINE ISSN 1311-0179 (Print) ISSN 2815-3723 (Online)
National issue for science and practice
© Publishing house „Hranitelno-vkucova promishlenost”
With the assistance of University of Food TechnologiPlovdiv, Agricultural Academy at the Ministry of Agriculture

Editorial board: Prof. Chavdar Damianov DSc., Assoc. Prof. George Djatov, Prof. Jordan Gogov, Jana Velichkova, Assoc. prof. Kiril Mihalev, Dipl. eng. Magdalina Gadjeva, Petko Delibeev, Ph.D., Prof. Stefan Dragoev DSc, Corresponding Member of the BAS, Ph.D. Svetlana Minkova, Prof. Veselka Duleva DSc., Assoc. Prof. Valentina Bagdasarian
Editor-in-Chief: Petko Delibeev, Tel.: + 359 2 988 05 89; e-mail: info@fpim-bg.org
Advertisement: Violeta Georgieva Tel.: + 359 2 988 05 89; e-mail: fpim_adv@abv.bg
Design: Zora Yancheva, Tel.: + 359 2 988 05 89, е-mail: dizart@abv.bg
Address: BULGARIA, 1000 Sofia, 108 Rakovsky Str., fl. 6, office 605, Tel./Fax: +359 2 988 05 89; GSM: +359 88 4646 919; e-mail: info@fpim-bg.org
Printing: Voodoo Print LTD; www.voo-doo.eu
С o n t e n t Сontent
24
„ХРАНИТЕЛНО-ВКУСОВА ПРОМИШЛЕНОСТ”
Year LXXI Issue 6/2022
®
на статиите. Абонамент чрез Български пощи и „Доби прес” АБОНИРАНЕ В РЕДАКЦИЯТА ПРЕЗ ЦЯЛАТА ГОДИНА !
26
индус трия Самите български предприятия са модерни, оборудвани с последни техноло гии, които отговарят на всички изисквания на ЕС и международните стандарти за качество и безопасност. Около 70% от месните продукти се произвеждат от топ 25-те месопреработва телни предприятия в България. Основният про блем са суровините за месната индустрия. Спо ред официалната статистика, през 1989 година в България е имало 1 613 116 говеда, през 2010 г – 544 хиляди говеда, а през 2019 – 510 хиляди Свинете през 1989 г са 4 118 000, през 2010 г са 664 хиляди, а през 2019 броят им е 491 814. Независимо, че държавата непрекъснато суб сидира животновъдството, няма достатъчно су ровина за месната индустрия

ни в последните няколко години кризи поставиха на изпитание световната икономика.И докато днес във фокуса е енергийната криза, в началото на епидемията сериозен въпрос бе предотвратяването на продоволствената криза. А такава изпитаха в различна степен и развити държави. И трябва да сме благодарни на нашата промишленост, че в България нямаше празни рафтове в магазините. С тези размисли, а и по повод преизбирането му за председател на Асоциацията на месопреработвателите се срещнах с Атанас Урджанов преди поредното онлайн заседание на Управителния съвет. И предвид безпрецедентната криза, в която работи цялата ни икономика, започнахме разговора си с кратък преглед на състоянието на сектора в момента:
1995-1998 г. – спад в производството на месо поради намаляване броя на животните, липса на финансови ресурси, голяма задлъжнялост, загуба на традиционни пазари, намаление на вътрешното потребление За съжаление 23 години по-късно проблемите продължават и рисковете за бизнеса се разширяват и задълбочават. Сред проблемите трябва да бъде посочено предизвикателството в подготовката на млади кадри за индустрията, както и тяхното дълго срочно задържане в нея. По данни на Нацио налния осигурителен институт броят на осигу рените лица в сектора е 17 726 за периода януа ри юли 2021 г., като 20% от заетите в сектора са на възраст над 55 години Условията на работа в месната индустрия са при ниски температури (12 °С) и технологична влага. Младите хора не желаят да работят при такива условия. По ини циатива на АМБ, единствените две паралелки в професионалните гимназии
стратегия е от периода 1999-2001 г., която е търсела ре шения на възникналите проблеми в периода
5 6/22 интервю Близо 20% от производството на храни телни
. В чисто управленски план – от години се чувства недооценяване на стратегическата роля на животновъдството и системните връз ки с много индустрии, които твърде дълго вече не могат да разчитат на подкрепа Прозрачна, системна, дългосрочна подкрепа от държавата, във всичките й роли от законодателната, през здравната, до митническата и данъчната поли
. Многократно поставяме пред институ-
въпроса, че няма стратегия за
Последната държавна
продукти в страната е относител ният дял на българската месна
тика
циите
месната индустрия.
у нас със специ алност „Производство на месо, месни продукти и риба“ (в Плевен и София) – бяха определени от МОН като защитени професии Индустрия та се развива много динамично по отношение Необходима е стратегия за месната индустрия у нас Визитка: Атанас Урджанов е икономист по образование. Има 30-годишен стаж в месопреработката в едно от водещите предприятия в страната. Той е първият председател на Асо циацията на месопреработвателите в България избран за трети последователен мандат Зам.-председател е на Бюро то на Съвета на браншовите организации към Българската търговско промишлена
палата и зам.-председател на Упра вителния съвет на Съюза по хранителна промишленост. Сполетелите
на нови техники и технологии и се нуждае от кадри с нови знания, умения и компетенции.
Трябва да посоча и обстоятелството, че връзка та между бизнеса и учебните заведения е трай
но прекъсната С годините се задълбочава тенденцията за разминаване между потребностите на икономиката и профила на кадрите, които подготвят средното и висшето образование. Има какво да се подобри в много направления: при планирането на приема в учебните заведе ния да се отчитат актуалните потребности на икономиката; да се изгради система, която да отчита реализацията на завършващите специа листи Отчитайки променящите се демограф ски тенденции и застаряването на работната сила, ние в бранша работим за приемственост и трансфер на знания и умения между поколе нията, както от по младите към по възрастните, така и обратно. За да се отговори на предизви кателствата в сектора е необходим нов начин на професионално образование и обучение. То трябва да е гъвкаво и хармонизирано с изис кванията на пазара на труда
Категоричен факт за дееспособността на нашата хранителна индустрия е това, че българският потребител и в най-върховите моменти на кризата бе задоволен с хранителни продукти. Как оценявате ролята на държавата за подпомагане развитието на сектора „Месопреработване“? Изискванията за безопасност към храните от животински произход, каквито са месото и месните продукти, са значително по високи в сравнение с тези към неживотинските храни В зависимост от оценката на риска в месопре работвателните предприятия се осъществява официален контрол от компетентните органи. А в кланиците контролът е постоянен, ежедневен. Всички регистрирани от БАБХ предприятия от бранша са направили наистина значителни
на месни продукти. Това налага непрекъснато въвеждане на нови технологии и процеси, оп тимизиране на производството, с цел здраво словно хранене, опазване на околната среда, адаптирането на маркетинговите и рекламните стратегии, като се вземат предвид нуждите на най уязвимите За да отговорим на предизвикателствата за чиста, кръгова икономика, възстановяване на биологичното разнообразие и намаляване на замърсяването, ще е необходимо да инвестира ме нови и нови ресурси в иновации, технологии и устойчиви храни. Представителите на бранша трябва да полу чат възможности за подкрепа и тук е мястото да спомена, че принципите и политиките на стра тегията „От фермата до трапезата“ са една въз можност за подобряване на начина на живот, на здравето и на околната среда. Опаковките на храните също са обект на по литики и трайни решения, защото играят клю чова роля за устойчивостта на продоволстве ните системи Тенденция е при опаковането на месото и месните продукти все повече да се из ползват опаковки, подходящи за рециклиране и щадящи околната среда Вашата браншова организация е сред найактивните в отрасъла. Кои дейности бихте отбелязал като стремеж на Асоциацията да помага на фирмите, а и на държавата, за подобряване на съществуващия бизнес-климат у нас? Това, че Асоциацията на месопреработва телите в България е единствена браншова ор ганизация в своя сектор, говори достатъчно за авторитета, който сме извоювали през измина лите 28 години от създаването си. Работим в много направления. От една стра на развиваме контактите между бизнеса и учи лищата, като подпомагаме приемането на учеб ни програми релевантни към потребностите на бизнеса, а от друга страна подпомагаме всячес ки подготовката на младите кадри с практичес ки модели
6 6 /22 интервю
ин вестиции, за да изпълнят високите изисквания на европейското и националното законодател ство Но този контрол е само за регистрирани те, за законните предприятия. За съжаление, „сивия сектор“ никой не го контролира. На свой ред, непрекъснато променящото се законодателство по отношение безопас ността на храните, хуманното отношение към животните и т н изисква да продължаваме да инвестираме в подобряване на сградния фонд, оборудването, въвеждането на нови техноло гии За съжаление обаче, за преработвателната индустрия няма подпомагане нито от държава та, нито от европейски програми (с едно изкл. подмярка 4.2. от ПРСР). Браншът ни е изправен пред редица пре дизвикателства за устойчиво производство
но
технически. Развиваме
ността на
. От тради циите в рецептите и вкусовите достижения на българското производство до представянето на българските месопреработватели в различ ни професионални форуми, в медиите, в пред ложенията към държавните институции, къде то нерядко намираме разбиране, а понякога и подкрепа. Сред активностите ни е политиката по ДДС на държавата и намирането на предложения за оптимизирането й, така че българските месоп реработватели да бъдат конкурентоспособни
и стажове. Помагаме организацион
,
знанието на обществото за цен
родната месопреработка
на европейските, но и на всички други пазари. 20% ДДС прави неконкурентоспособни българските месни продукти пред европейските. От 24 държави-членки на ЕС само в 5 държави няма намалена ДДС ставка на месото и това са: България, Дания, Литва, Латвия, Естония – (нямаме данни за Малта, Люксембург и Кипър). В Словакия не е намалена ДДС ставката на замразеното месо и преработените проду кти, но на прясното месо тя е 10%. В Ирландия и Великобритания ДДС на месото и преработени те продукти е 0%. В Швейцария при стандартна ДДС ставка 7,7%, ДДС на месото и преработени те продукти е 2,5% ДДС на месото и прерабо тените продукти в Унгария и Полша е 5%, във Франция 5,5%, в Белгия и Португалия – 6%, в Германия – 7%, в Румъния и Нидерландия – 9%, в Словения – 9,5%, в Испания, Италия и Австрия 10%, в Гърция – 13%, в Черна гора – 7%, в Тур ция – 8%, в Сърбия – 10%.
С какви конкретни дейности подпомагате фирмите, членове на АМБ и техните специалисти?
Най напред ще отбележа, че АМБ е един ственият издател на специализирана литера тура в областта на месната индустрия. Нашите 11 сборника съдържат традиционни български рецептури и технологии, наръчници и ръковод ства.
Експертите ни провеждат обучения и раз работват системи за самоконтрол за обекти за производство и търговия с храни (добри прак тики, НАССР, проследяемост, сензорен анализ и др )
Извършваме консултантска дейност в облас тта на законодателството в сферата на храните (етикетиране, определяне на хранителни стой ности, обозначаване на страна на произход). Провеждаме и вътрешни одити на системите за управление на безопасността на храните в предприятията Представляваме българската месопрера ботвателна индустрия в специализирани изло жения в страната и чужбина с цел повишаване конкурентоспособността й и разширяване на пазарните позиции на българските месни про дукти. Последното правителство се опита да възроди идеята за Закон за браншовите организации, но съществува доста кратко време, за да реализира тази отколешна идея. Как виждате бъдещето пред дейността на браншовите организации в отрасъла при настоящата ситуация? Ще продължаваме да настояваме за Закон за браншовите организации, в който освен за дължения, да се разпишат и гаранции, и права,
и държавна подкрепа. Практика е администра цията да включва браншовите организации в различни работни групи и консултативни съ вети, но участието им е в повечето случаи само със съвещателен глас и решенията за бизнеса се вземат от администрацията А браншови те организации са тези, които следва да имат право да участват при вземане на решения по законодателството и стратегиите. Например в Германия никой няма право да започне дей ност, свързана с месопреработка, без да члену ва в професионална браншова организация. И поради конкуренцията помежду им, произво дителите се стремят да спазват етичните норми и имат по голям респект от браншовата органи зация Най-важните задачи пред Асоциацията на месопреработвателите, които предстоят в новия Ви мандат? Хранителната индустрия е бизнес сектор от стратегическо значение за всяка икономика. Това обясняваме на всички държавни ръково дители Ежедневно Докато не осигурим заслу женото институционално уважение към индус трията, към фирмите в месопреработката у нас, към нашите служители и уважението към бъл гарските месни продукти ще продължаваме. Това е основната ми задача, но и на всички нас. Бизнесът иска спокойна среда, в която не само да се опитва да поддържа работни места, но и да се развива. При това да се развива не само в България, но и регионално, като българските знания, опит, рецепти и месни продукти станат традиционна част от трапезата в други страни. Въпреки предизвикателствата на непред видимата ситуация днес, активно търсим нови перспективи за развитие. Ще продължаваме активно да участваме в работни групи и съвети, ще изпращаме своите знания и опит под фор мата на мотивирани становища по проблеми, свързани с бранша От АМБ ще продължаваме да акцентираме върху ролята и отговорността на българските медии за прецизното информиране по отно шение българските месни продукти. Неточни, неясни медийни твърдения дори само в марги нални медии или в медии
7 6/22 интервю
с локално
ние могат да попречат на маркетинга на българ ските месни продукти не само на
, но и на европейските пазари Такова нашенско, родно подценяване на високото качество на българ ската месопреработка не трябва да допускаме в медиите. Бъдещето на България стъпва и на хранителната индустрия на страната и на ней ната конкурентоспособност в регионален и глобален план. Петко Делибеев
само
влия
нашия
пилешки продукти се предлагат в четири разновидности: оригинални леко панирани нагети, леко панирани ивици, биволски нагети и би волски лентички. Предложенията са 100% без зърно и глутен и съдържат 3-4 гр. нетни въглехидрати и 23 гр. протеин в порция. Брайън Фрийман, изпълнителен председател на Real Good Foods, заявява: Тези апетитни парченца и лентички са резултат от нашата мисия да направим любимите ни храни по-вкусни, по-хранителни и да подобрим човешкото здраве. Нашите вкусни пилешки нагетс и лентички са направени без добавена захар, въглехидрати и преработени зърнени храни, които се срещат в други храни. Вместо


пълни

8 6 /22 новости Марката за снаксове Mindright представи на пазара най новата си иновация, „първата по рода си“ гама от чи псове с ноотропни съставки, стимулиращи мозъка. Нова та серия се предлага в три вкуса – чили лайм, канела и куркума. Чипсът се приготвя с помощта на характерната за мар ката ноотропна отвара, която съдържа женшен, лъвска грива (гъба „игловиден корал“) и L теанин, както и вита мини В6, В12 и антиоксиданти, които влияят благоприятно на енергията, настроението и концентрацията Чипсът е със 100% масло от авокадо, вместо с традиционните масла от рапица или соя Крис Бърнард, съосновател и главен директор в Mindright, заявява: Гледали ли сте някога съставките на чипса в торбичките? Ние погледнахме, помислихме и направихме закуската по-добра с лансирането на нашата последна
оцветители и ароматизатори. Брандът First We Feast›s Hot Ones разшири партньорството си с John Soules Foods и FoodStor y Brands, за да дебютира с пет нови вкуса пилешки хапки без кости. Новите Hot Ones Boneless Chicken Bites се предлагат в за тварящи се торбички от 18,6 унции (1 унция= 28,35 g.), във всяка от които е добавен пакет сос Hot Ones. Петте нови варианта включват: оригинален, съчетан с класически сос; ароматен чесън, съчетан с класиче ски чеснов сос; пушено сладък в комбинация със сос Los Calientes Verde; пушен с люта чушка Хабанеро в ком бинация със сос Los Calientes Rojo; и Барбакоа в комбинация със сос Los Calientes Barbacoa. Крис Шонбергер, генерален мениджър на First We Feast, заявява: Доволни сме да разширим вкусовите си възможности с пет от най-популярните сосове Hot Ones. Нашата цел е да направим преживяването с Hot Ones достъпно за почитателите, както и да запознаем новите си клиенти с вкусове, които няма да намерят никъде другаде в магазините за замразени храни. https://www.foodbev.com/ Ноотропни чипсове на пазара Производителят на замразени храни Real Good Foods разшири портфолиото си с пускането на два нови продукта – панирано пилешко месо, пилешки хапки и лентички. Панираните
теини и имат
количество въглехидрати. Панирано пилешко с много протеини и малко въглехидрати Обезкостени пилешки хапки със сос
иновация – първата по рода си чипсова закуска, в която са вложени ноотропи и супер храни. – и продължава: Чипсът е вегетариански, с ниско съдържание на захар и без млечни продукти, глутен, зърнени култури, консерванти и изкуствени
това те са
с про-
ограничено


































Промените в морските аквато рии, породени от системното им замърсяване с токсични промиш лени и битови отпадъци се отразя ва негативно върху състоянието на водните екосистеми Тези промени имат освен икономически изме рения и важно хигиенно здравно значение върху рибните попула ции, обект на промишлен риболов. От антропогенните замърсите ли най голяма роля имат тежките токсични метали Те се отличават с нисък праг на токсичност и широк спектър на увреждания. На първо място сред тях се нарежда жива кът Той се открива


ресурси по отношение на токсично въздейст


на живака върху рибите и чо века Европейската комисия (EK) и Европeйският орган по безопас ност на храните (EFSA) публикуват подробни анализи и документи, с оглед превенцията на токсичните увреждания на човешките попула ции, предизвикани от консумаци ята на замърсена риба с метилжи вак (7,8,9) Х и м и ч н а Химична х а р а к т е р и с т и к а характеристика Живакът
популации. Неговият период на полуразпад е около 72 дни и създава условия за биоакумулация Метилирането на живака е биологичен процес, кой то протича под въздействието на сулфитредуциращи и желязоре дуциращи бактерии Процесът се влияе от редица фактори, които си взаимодействат и са в зависимост от активността на посочените гру пи микроорганизми и концентра цията на бионаличния живак. От съществено значение за протича нето на процеса на метилиране са стойностите на

10 6/22 актуално
в тинята, утай ките, отпадните води и планктона във водата на моретата и океани те. Чрез хрилете и кожата живакът прониква и се натрупва в тялото на рибите (2) Проучванията в редица страни свидетелстват, чe в региони къ дето населението консумира зна чително количество риба се на блюдават хронични заболявания, свързани с токсично увреждане на организма предизвикано от ме тилживак.(1) Във връзка с актуалността на проблема, свързан със замърся ването на водните пространства с живак и контролът върху еко системите
е течен сребристобял метал с атомна маса 200,59, точка на топене 38,87оС, точка на кипене 356,58оС и относителна маса при 20оС – 13,546. Притежава относи телно висока електро и топлопро водимост както и значителна хи мична устойчивост и плътност. (1) Той се отделя в околната среда по естествен път или от антропогенни източници Отделеният живак пре търпява редица сложни трансфор мации. Изследванията показват, че живакът в природата се среща в три основни форми: елементарна (метална), неорганична и органич на Най често срещаната форма на органичен живак е метилживака. За разлика от неорганичния жи вак, метилживакът е силно токси чен за човека Той се генерира във водните системи и не се елимини ра бързо от рибните
рН, температурата, редоксипотенциала на средата, както и от наличието на органични и неорганични комплексообразу ващи вещества Абиотичното ме тилиране на живака е химически процес и се определя от присъст вието на подходящи метални до нори. Като положително зареден йон метилживакът лесно се свърз ва с аниони като хлориди, хидрок сиди, нитрати и др., но има особе но изразен афинитет към серните аниони. Освен метилживака, като силно токсично живачно съедине ния се счита и етилживакът П о в и ш е н о т о Повишеното с ъ д ъ р ж а н и е съдържание н а м е т и л ж и в а к на метилживак в р и б и т е – в рибите –с е р и о з е н р и с к з а сериозен риск за ч о в е ш к о т о з д р а в е човешкото здраве Проф. д-р Йордан Гогов
и рибните
вие
изгаряне на ток сични промишлени и битови от падъци, съдържащи неорганичен живак. Източник на замърсяване са и отпадните продукти от рудо добива, въгледобивните мини, из гарянето на торф, нефтопродукти, природен газ и дървесина. Като рискови отпадъци за неорганичен живак се считат също промишле ните отпадъци от галванотехни ката, луминесцентните лампи и военната индустрия. За особено рисково се определя производ ството на ацеталдехид. Замър сителите, съдържащи различни количества живак, се пренасят ди ректно в морските акватории чрез изпускателни съоръжения или с реките вливащите се в моретата и океаните. Токсичните отпадъци се разполагат по дъното на водоеми те във вид на утайки или в тинята (2). Морските тече ния и вълните способстват за разпространението на живака във всички части на водния стълб Наблюде нията показват, че живакът се натрупва чрез храни телната верига в рибните популации, като най за

























в и е в ъ р х у ч о в е к а вие върху човека Интоксикацията с живак про тича в остра и хронична форма. При острата форма се наблюдава гастроинтестинален синдром с проява на интензивно слюноот деляне, болки зад гръдната кост, метален вкус, повръщане, кървава диария, отоци и язвени промени във венците. Наред с това се от крояват прояви на обща отпадна лост, намалено отделяне на урина и остра бъбречна недостатъчност По често се среща живачна ин токсикация в хронична форма, която се демонстрира с признаци на неврастения, повишена умора, раздразнителност, понижение на паметта и упорито главоболие По късно се наблюдава прогре сиращо треперене на ръцете с невъзможност за изпълнение на ръчни операции Установяват се и функционални разстройства на
ендокринните жлези (щитовид на и полови жлези). Промените в сърдечно съдовата система се из разяват с изменения на сърдечния ритъм (тахикардия, аритмия), глу хи сърдечни тонове и спазъм на капилярите (1) За първи път през 1956 г в Япо ния са регистрирани случаи на живачна интоксикаця сред хора от залива Минамата. Преди това в същия регион е наблюдавано многократно изплуване на мъртва риба, както и пристъпи на „лудост“ и удавяния на котки консумирали риба, замърсена с живак. При хо рата са констатирани прояви на атаксия, обща мускулна слабост, парализа, както и увреждане на слуха и речта. Тези неврологични симптоми са били интерпретира ни като характерни за множестве на склероза. По късно е доказано, че тези болестни признаци се дъл жат на метилживак, съдържащ се в промишлените отпадъци от едно промишлено предприятие Замър сяването е продължило повече от 30 години, в резултат на което зна чително количество метилживак е бил акумулиран в морските хидро бионти, обект на улов в залива Ми

актуално ПОДЕМНО-ТРАНСПОРТНА ТЕХНИКА КОМПЛЕКСНИ ЛОГИСТИЧНИ РЕШЕНИЯ , СКЛАДОВА ТЕХНИКА ЗА ХРАНИТЕЛНО-ВКУСОВАТА ПРОМИШЛИНОСТ Специализирана техника за професионално почистване на индустриални, складови и търговски площи. Иновативни решения, подходящи за хранително-вкусовия бранш. И з т о ч н и ц и н а Източници на р а з п р о с т р а н е н и е разпространение Естествени източници на неор ганичен живак в околната среда са горските пожари и активната вулканична
сегнати са едрите хищни и дънни риби Глобалното затопляне на морските ак ватории повишава енер гийните нужди на дреб ните риби, при което те се хранят обилно и натрупват в организма си живак От друга страна едрите хищни риби като акула, риба меч, риба тон, камбала, марлин, зубан, едър атлантически зарган, треска и др по глъщат по дребните и така увеличават количеството на органичния живак в тялото си. Концентрацията на живак в отдел ните видове риби е в пряка зави
То к с и ч н о в ъ з д е
с
Токсично
дейност в определен географски региони. Сериозен проблем е антропо генното замърсяване на природа та в резултат на
симост от техния размер, възраст, и вида на обитавания водоем
й
т -
въздейст-
и от 1,3 μg/kg т.т. за
тилживак (и двете изразени като живак) Основанието за това е, че нивото на експозиция чрез храна та в 95-ия процентил е близо до или над ПСП за всички възрастови групи. При консумиращите значи телни количества риба, сред които и бременни жени, е възможно да се достигне до шесткратно преви шаване на ПСП. Неродените деца съставляват най уязвимата група. Наред с това на 27 юни 2014 г. ЕFSА прие становище относно ползите за здравето от консумацията на морски храни спрямо рисковете свързани с експозицията на метил живак (9). В посоченото становище е направен преглед за ролята на морските храни в европейските хранителни режими и е оценено положителното въздействие на консумацията
изявление (10) относно ползите за човешкото здраве от консумацията на риба/морска хра
, като ги съпоставя с рисковете от присъствието на метилживак в рибните хидробионти, използвани като храна. На база становищата на ЕFSA от ЕК е извършен преглед на мак симално допустимите количества живак в рибите и с Регламент (EC) 2022/617 (5) са
(EС) 2022/1342 (3) ЕК препоръчва през периода 2022 – 2025 г на държа вите членки да извършват монито ринг за наличието на метилживак и общ живак в риба, ракообразни и мекотели Мониторингът следва да включва различни видове риба, ракообразни и мекотели (диви популации и аквакултури), както и да отразява навиците на потре бителите, за да се постигне точна оценка
, свър
замърсени с токсичен живак Друг важен документ е Конвен цията от Минамата (6), който пред ставлява международен договор по линия за защита на човешкото здраве и околната среда от ан тропогенни емисии и изпускане на живак и живачни съединения. Конвенцията е подписана на 19 януари 2013 г. в Женева и e пре подписана през същата година на 10 октомври на дипломатическата конференция в Кумамото, Япония Литературни източници 1 Бояджиев, В., Цв Алексиева, З Запрянов, Й Хаджиева, М Колева, Н Цачева, П . Бояджиева, П . Николова, С. Иванова, Т. Кунева. 1990, Отравяния с тежки метали, С., Медицина и физкул тура, 242 с
2. Стоянов, С., 1999, Тежки метали в околната среда и хранителните про дукти Токсично увреждане на човека Клинична картина. Лечение и профилак тика Пенсофт, София, 288 с
3. Commission Recommendation (EU) 2022/1342 of 28 July 2022 on the monitoring of mercur y in fish, crustaceans and molluscs. OJ L 201, 1.8.2022, p 71
4. Commission Regulation (EC) No 1881/2006 of 19 December 2006 setting maximum levels for certain contaminants in foodstuffs. OJ L 364, 20.12.2006, p 5.
5. Commission Regulation (EU) 2022/617 of 12 April 2022 amending Regulation (EC) No 1881/2006 as regards maximum levels of mercur y in fish and salt . OJ L 115, 13.4.2022, p. 60.
6. Minamata Convention on Mercur y, Kumamoto, Japan, 2013.
7. Opinion of the Scientific Panel on Contaminants in the Food Chain on a request from the Commission related to mercur y and methylmercur y in food. The EFSA Journal, 2004, 34, 1 14.
8. Scientific Opinion on the risk for public health related to the presence of mercur y and methylmercur y in food. EFSA Journal 2012;10(12):2985.
9. Scientific Opinion on health benefits of seafood (fish and shellfish) consumption in relation to health risks associated with exposure to methylmercur y. EFSA Journal 2014;12(7):3761
10. Statement on the benefits of fish/ seafood consumption compared to the risks of methylmercur y in fish/seafood. EFSA Journal 2015;13(1):3982.
12 6/22 актуално намата. През този период са почи нали много хора от региона, които са консумирали замърсена с ме тилживак риба Днес тази болест е световно известна като „Болест на Chissso Minamata“ . М о н и т о р и н г в ъ р х у Мониторинг върху е к с п о з и ц и я т а н а м е - експозицията на мет и л ж и в а к в м о р с к и тилживак в морски х р а н и храни На 22 ноември 2012г. EFSA прие становище относно живак и метилживак в храните (8). В това становище се определя приемлив седмичен прием (ПСП) от 4 μg/kg телесно тегло („т.т.“) за неоргани чен живак
на морски храни върху човешкото здраве, включи телно и по време на бременност EFSA стигна до заключението, че консумацията на около 1-2 пор ции морски храни седмично и до 3-4 порции седмично по време на бременност се свързва с по добри функционални показатели за не врологично развитие на децата в сравнение с тези, които не консу мират морски храни. Посочените количества се свързват и с по ни ска смъртност от коронарна бо лест на сърцето при възрастни През 2015 г. ЕFSA публикува специално
направени измене ния на хигиенните норми за живак в риби и сол в Регламент
№ 1881/2006 (4) Актуалните максимално допус тими количества живак в риба и други хидробионти са конкретизи рани в Приложение I, т 3, подточка 3.3. на Регламент
№1
П р е п о р ъ к и н а Препоръки на Е в р о п е й с к а т а Европейската к о м и с и я комисия Съгласно Регламент
на експозицията на живак при консумация на хидробионти те. За целта държавите членки е необходимо да организират спе циални национални съвети за по требление на риба, ракообразни и мекотели с цел да се постигне пълноценно въздействие върху честотата на предпочитаната за консумация риба и морска храна и да се ограничат рисковете от при съствието на токсичен живак Целесъобразно е държавите членки, стопанските субекти в об ластта на храните и другите заин тересовани страни непрекъснато да информират потребителите и съответните здравни работници, които работят с групите рискови потребители
ме
на
(ЕС)
(EC)
881/2006.
за опасностите
зани с консумацията на хидроби онти,





13 6/22 Flowfresh Newspaper Advertisement curves indd 1 Newspaper Advertisement_curves.indd 1 09 09 2022 09:38:30 09.09.2022
крайбрежните и вътрешните води. Аквакултурите и хранителната система на бъдещето

водни системи на Земята
храна от водна среда, трябва да практикуваме разумна и устойчи ва аквакултура Под аквакултура се има предвид контролираното отглеждане на во дни животни и растения като риби, миди, морски треви и водорасли във водни среди, и днес именно аквакултурата е най бързо разраст ващото се производство на храни в света Поради тази причина секто рът се оказва изправен както пред предизвикателства, така и пред въз можности Отрасловият растеж има потенциала да се справи с несигур ността в изхранването на увелича ващото се население на планетата, но
, изключи телно подходящо за стимулиране и подкрепа на иновациите в сферата на аквакултурата От 2018 г глобал ното производство на аквакултура е отбелязало ръст от 228 процента, а от 1995 г. стойността на сектора се е увеличила с 492 процента 1995. Този растеж предлага на аквакултурата
повече възможности
бизнес
14 6/22 тенденции
в
Всички
са
но
правим на дадено място, би могло да окаже пряко въз действие върху екосистемата друга де Нашите океани и водни пътища са в опасност и за да гарантираме, 1 Обогатяване на водата с хранителни вещества, особено с азотни и/или фосфорни съставки, при което се предизвиква силен
на водорасли и висша водна растителност и в резултат се поражда
водите – б.р. че
за да бъде практикувана устойчи во, аквакултурата следва да отгово ри на редица критерии Това означава, че компаниите трябва да проявяват социална отго ворност в подкрепа на широк кръг хора и на техния поминък както на общо корпоративно, така и на по ниско ниво; важно е обаче да се отбележи, че в случая
говорим за жизнеспособна
И н о в а ц и и т е в Иновациите в у с т о й ч и в а т а а к в а к у л т у р а устойчивата аквакултура Както споменах в подкаста на New Food (епизодът от юли 2022 г.) Food to Go, живеем във време
все
да
С продължаващото нарастване на търсенето на храни от морски произход все по-очевидна става и необходимостта от устойчиви практики в сектора. В първия от поредица материали главният изпълнителен директор на EIT Food д-р Анди Зигна акцентира върху спешната потребност от устойчива аквакултура – и какво по-точно включва въпросното понятие. Интересът към изделията от морски дарове, водни растения и животни се увеличава с невероят на скорост, което оказва огромен натиск върху хранителния отрасъл, принуждавайки го да намери устой чиви начини да не изостане от нало женото темпо. Средната консумация на глава от населението на морски храни е нараснала от 9 килогра ма годишно през 1961 г до над 20 килограма за година към 2019 г В резултат, приблизително две трети от световните рибни запаси или се експлоатират до възможния пре дел, или вече са станали жертва на прекомерен риболов и към момен та се намират в криза. Неустойчи вите действия, подобни на току що описаните, биха могли да нанесат огромни вреди на екосистемите и хабитатите, причинявайки опусто шително замърсяване на океаните и не по малко опасна еутрофикация1 несе за преодоляването на някои от най сериозните предизвикателства
взаимосвързани и следовател
онова, което
растеж
нежелано нарушаване на равновесието на намиращите се във водната среда организми, както и влошаване на качеството на
всеки може да продължи да кон
сумира
безспорно
възможност
Също така, продукцията от ак вакултура следва да бъде не само полезна за човешкото здраве и бла годенствие, но и добивана по начин, който не води до значителни вреди за екосистемите Това включва под държане на здравословна среда и високи стандарти за благосъс тоянието на отглежданите видове, използване на устойчиви фуражи и гарантиране на участието на ак вакултурата в по широката кръгова икономика
допри
комер сиално



храни за риба представляват брашно от смляна риба и рибено масло Производство то на подобни фуражи е ресурсно интензивно: в момента огромно ко личество риба се лови единствено с цел направа на храна за друга риба Това води до свръхриболов на попу лации от по малки „фуражни риби“ от сорта на аншоа и херинга, вла гани в производството на храна за комерсиално отглежданите видове риба За съжаление, оттук произти чат още редица последици за цяла та екосистема, тъй като, например оцеляването на по големите риби в моретата и океаните ни също зави си от наличието на „фуражна риба“, с

която те да се хранят. Това поставя риболова и аква културата в центъра на един цикъл, при който риба се лови прекомерно с единствената цел да се произвеж да повече риба, и прави очевидна спешната нужда от алтернативни, устойчиви фуражи за риба В по следно време наблюдаваме засилен интерес в използването на алтерна тивни растителни протеини и масла, съдържащи здравословни Омега-3 киселини, които заменят рибеното брашно във фуражите Значителен потенциал има и пред влагането в храните за риба на култивирани на секоми
Друга алтернатива предлагат ми кроводораслите, които се налагат като все по популярен елемент във фуражните смески благодарение на незначителния си въглероден от печатък, бърз растеж и подходящ хранителен профил Те разполагат с високо съдържание на протеин, богати са и на хранителни влакна, микронутриенти и биоактивни със тавки. Aliga Microalgae, базирана в Дания компания в областта на хра нителните технологии, разработва, култивира и произвежда богати на протеин и функционални ингреди енти от микроводорасли именно за приложения в областта на аквакул
тенденции на днешния ден – като хранителна несигурност, климатични промени и здравно неравенство, а това от своя страна стимулира иновациите в сек тора. И з н а м и р а н е н а Изнамиране на у с т о й ч и в и ф у р а ж и з а устойчиви фуражи за р и б и т е рибите Едно от най сериозните предиз викателства
пред аквакултурата е нуждата от устойчиви фуражи. По настоящем мнозинството от
предлаганите
У н а с У нас Над 20 млн евро за инвестиции са предвидени в новата програма за морско дело, рибарство и аквакултури
105 от язовирите са с национално значение, а над 270 са пъстървовите сто панства, 4 от които са големи В морето има 24 разрешителни за ферми за миди, но реално функционират по малко, а само 2 са големи Около 15 хил. тона риба и миди произвеждат стопанствата, приблизително толкова – около 13-14 хил. тона е от риболов. Общият бюджет на Програмата за морско дело, рибарство и аквакултури 2021-2027 г. е 115 298 млн. евро, от които 70% са от европейския фонд, а 30% е национално съфинансиране.
, която неотдавна България из прати към ЕК През последните години непрекъснато намалява уловът от океаните и моретата, а в същото време се увеличава търсенето на риба от потребителите Затова ЕС стимулира отглеждането на аквакултури
турата Един от техните продукти, произведен за нуждите на рибар ниците, е Aquapaste, представляващ концентрирана паста от високохра нителни водорасли Chlorella. Базираното в Исландия пред приятие Vaxa също се фокусира вър ху микроводораслите в качеството им на устойчива храна за риба Vaxa интегрира микроводорасловата си аквакултура с една от най големи те в света геотермални централи, позволявайки й да трансформира страничния продукт от централа та в устойчив ресурс в процеса на производство на микроводорасли, което го прави част от една важна кръгова икономика Така получе ните микроводорасли могат да на мерят приложение под формата на устойчив фураж за риба, но и като нова категория богати на протеин и Омега-3 продукти за човешка кон сумация, включително хранителни добавки, естествени оцветители и протеини за подсилване на месните заместители

секторът на аквакул турата несъмнено ще се изправи пред нови предизвика телства Растежът на устойчивите аква културни практики и иновациите в сек тора обаче недвусмислено сочат, че потребителите в глобален план са все по склонни да се възползват от достъпа до здравословни храни от воден произход, богати на про теин и микронутриенти В контекста на измененията на моделите на по требление по света аквакултурата


по всяка вероятност ще играе зна чима роля в бъдещето на нашата хранителна система. От решаващо значение е всички ние да продължим да подкрепяме бизнесите и предприемачите в тази област, така че иновациите да съ




, устойчиви решения на огромните, свързани с храните предизвикателства, пред които днес е изправен светът. Нуж но е всички гласове да бъдат чути и на идеите за всяка част от хранител ната система да бъде даден шанс за реализация, така че да продължим да произвеждаме и да се наслажда ваме на храната, която обичаме По https://www.newfoodmagazine.com/

създадат

16 6/22 тенденции
а к у л т у
а
Б ъ д е щ е т о н а Бъдещето на а к в
р
т а аквакултурата В перспектива
ПЪЛНАЧНИ , ЗАТВАРЯЩИ , ЕТИКЕТИРАЩИ , ФОЛИРАЩИ , ОПАКОВЪЧНИ МАШИНИ Машини произход Китай, Сертификат СЕ, сервиз, поддръжка и резервни части www.sanmax.info +359876989710 +3592 444 4902 умеят да отговорят на изискванията на това бъдеще. За целта е необхо димо всички елементи на хранител ната
заработят заедно, за
система да
да
новаторски
• Îïòè÷íî ïðèâëåêàòåëíè Ñëàéñîâå ñ ðàâíîìåðíî ïîêðèòèå îò ðàçëè÷íè ïîäïðàâêè - êðàñèâî îáêàíòâàíå
• Ðàâíîìåðíà îáâèâêà (îáøèâêà) ñ ïîäïðàâêè
• Ðàçëè÷íè ìàòåðèè (âêë. áàðèåðåí ìàòåðèàë çà òîïåí êàøêàâàë)
• Áîãàòî ðàçíîîáðàçèå îò âêóñîâè ëèíèè • Ëåñíî îáâèâàíå • Ïðèåìëèâî äåêëàðèðàíå • Áåç èçðîíâàíå ïðè íàðÿçâàíå (ñëàéñèðàíå)
ñòð. 13 на стр. 14 Òåìà çà ðàçìèñúë ÒÅÀ ÒÐÅÉÄÈÍà ÎÎÄ - îôèöèàëåí ïðåäñòàâèòåë íà WIBERG çà Áúëãàðèÿ Ñîôèÿ 1138, êâ. “Ãîðóáëÿíå”, óë. “Ëþëÿê” 9, òåë./ôàêñ: 02 974 50 01 ìîáèëåí: 0888 915 249, 0888 560 120; å-mail: teatrading@abv.bg www.teatrading.eu ÇÀ ÂÑÅÊÈ ÂÊÓÑ ÏÎÄÕÎÄßÙÀ ÎÁÂÈÂÊÀ ÄÅÊÎ ÊÓÈÊ® ÔÎËÈÎ ÇÀ ÊÀØÊÀÂÀË ÄÅÊÎ ÊÓÈÊ ® ÔÎËÈÎ ÇÀ ØÓÍÊÀ • Îò ôèííî ãðàíóëèðàíè äî íàòðîøåíè ïîäïðàâêè - ñìåñåíè ñ ïàð÷åíöà îò ïëîäîâå - äåëèêàòíà è êðàñèâà
îáâèâêà çà âàðåíè øóíêè • Äåêîðèðàíå ñ åäðî-íàòðîøåíè ïîäïðàâêè
• Èíäèâèäóàëíè âêóñîâå è öâåòîâå
ÄÅÊÎÐÈÐÀÙÈ ÏÎÄÏÐÀÂÊÈ
ÓÍÈÊÀËÅÍ ÎÏÒÈ×ÅÍ È ÂÊÓÑΠÇÀÂÚÐØÅÊ ÍÀ ÊÀØÊÀÂÀËÀ ÑÏÅÖÈÀËÈÒÅÒÈ ÎÒ ÌÅÑÎ Ñ ÂÊÓÑÎÂÅ, ÄÎÁÀÂÅÍÈ ×ÐÅÇ ÇÀËÅÏÂÀÙÈ ÔÎËÈÀ
ñ ìàøèíè
Какво е да работиш за лидер в производството на суровина, без която насъщният би бил немислим и каква е мисията в качеството Ви на ръководител на Лесафр България? Имам щастието да бъда дългогодишен съ трудник и партньор в световна компания с благородна мисия, отговорност към качество то и устойчива визия, посветена на опазването на природата и изхранването на планетата. Продължителният ми опит в рамките на компанията, първо във Франция, след това и у нас, превърна работата ми в мисия, която днес споделям с екипа си – да подсигурим жизнено важен продукт за производството на българ ския хляб. Без мая хлебозаводите не могат да работят, а към момента в България няма локално производство, така че приeмаме като своя отговорност снабдяването с
ни за приноса си в изхранване на населението по време на пандемия Вярвам в способността на Лесафр да отго варя на подобни предизвикателства, защото именно тук научих, че лидерството е въпрос на смелост, сърце, разум и желание за успех, вяра в своите качества и способностите на екипа.
Вашата оценка за ситуацията на българския пазар на хляба в момента и какво ни очаква през следващите месеци? Живеем в наистина интересни времена и докато говорим за технологичен напредък, не ограничени комуникационни възможности и прогрес в науката и бизнеса, в последните го дини си дадохме сметка, че наистина „Никой не е по-голям от хляба“. Свидетели

,
от различни
бяхме отличе
18 6 /22 интервю
този продукт, за да може всеки българин да има хляб на тра пезата си. Голям тест за тази наша мисия се оказа Ковид пандемията, но въпреки трудностите, които срещнахме, Лесафр България успя да отговори адекватно на многократно нарасна лото потребление на хляб в условията на из вънредната обстановка и осигури достатъчни количества мая за производството му Ком панията дори спечели отличието за „Успешно предприемачество по време на пандемия“ В съревнование с още шест
фирми
бизнес сектори в страната
ние
Нашият
на хляб, но брашното е основният компонент. България е голям производител на брашно и голям износител. В създалата се ситуация на усложнен достъп до суровини, в следващите месеци има риск да станем свиде тели на недостиг на брашно или да се наложи да го купуваме на многократно по високи цени „В Лесафр България приемаме хляба като своя мисия“ Лесафр България е част от Lesaffre Group – абсолютен пионер със 170-годишна експертиза във ферментационните процеси и един от лидерите на глобално равнище. Какво се случва понастоящем в бизнеса през погледа на Венета Писарска, генерален мениджър на Лесафр България?
сме на завръщането към автен тичния вкус и здравословната храна
продукт е жизнено важен за произ водството
ствие на събитията от февруари тази година, ос новните източници на меласа за територията на Европа не са достъпни и това създава много се риозен проблем за нашата индустрия, който из лиза дори извън рамките на Стария континент. Към момента обаче Lesaffre Group пра ви всичко по силите си, за да намира алтер натива за набавяне на меласа и да осигури производството на достатъчните количества мая, така че да гарантира нуждите на своите потребители Ние от екипа на Лесафр България се гор деем, защото сме локален представител на подобна сериозна международна структура, а и защото през годините си извоювахме по зицията на верен партньор. Вярвам, че към днешна дата всеки представител на хлебопро изводствената индустрия у нас би потвърдил ангажимента ни като доставчик и сътрудник и грижата ни на всяка българска трапеза да има хляб. В контекста на случващото се, ние от Лесафр България приемаме като своя мисия да доставим мая, квас и всички необхо дими за хлебопроизводството суровини, така, че хляб да има за всеки! www.lesaffre.bg



Проектиране, технология, монтаж

интервю в сравнение с предходни години. Поскъпване то на електроенергията и липсата на държавни субсидии за тази жизненоважна индустрия, ка квато е хлебопроизводството, може да доведе до съществено увеличение на цената на хляба или недостига му, породен от високите цени. Какъв е фокусът на Лесафр България в контекста на случващото се в световен мащаб и най-вече по отношение на ограничените количества на меласата? Както показахме по време на пандемията, така и сега, нашият основен
жане на трайно качествени продукти
обслужване за клиентите ни Правим
възможно, за да бъдем не
но
и
фокус е в поддър 0888623326 www.omegakbg.com office@omegakbg.com
и добро
всичко
просто доставчик,
верен партньор
, способен да отговори на техните нужди и изисквания. Бързата професионална реакция от наша страна, без стрес и колебания, е осно вен фактор да не загубим посоката си За цел та обаче е необходима сериозна подготовка, включваща многобройни симулации на извън редни ситуации. Такава е и настоящата с ограничените коли чества на меласата, която е остатъчен продукт от производството на захар и е от съществена важност за производството на маята. В след
сервиз на оборудване за хлебарство, сладкарство, пакетиращи машини, силозни стопанства и макарони
използват редактира


в генома на растението,
, те се превръщат във витамин Д3.
Д се създава в телата на хората след излагане на кожата на слънчева светлина, но въпреки това основният източник е храна та. Тази нова биоподсилена култура може да помогне на милиони хора с недостатъчност на витамин Д , което е нарастващ проблем, свър зан с по висок риск от рак, деменция и мно го причини, водещи до смърт. Проучванията показват също, че дефицитът
прием на витамин Д е 10 микрограма за възрастни При отглеждането на домати листата обик новено са отпадъчен материал, но тези от обо гатените растения могат да се използват за производството на веган добавки с витамин Д3 или за допълнително обогатяване на храната Показахме, че може да се обогатят доматите с провитамин Д3, като се използват редактирани гени, което означава, че доматите могат да бъдат разработени като растителен, устойчив източник на витамин Д3 – каз ва проф Кати Мартин, автор на изследването, което е отпечатано в Nature Plants. – Четиридесет процента от европейците имат недостиг на витамин Д, както и един милиард души по света. Ние не само се занимаваме с огромен здравен проблем, но помагаме на производителите, защото листата от домати, които в момента отиват за отпадъци, могат да се използват за приготвяне на добавки от генноредактираните линии. Предишни изследвания са показали био химичния път на това как 7-DHC се използва
20 6 /22 тенденции Изследователи
ни
молекула
която
мин
доматените
ва светлина
на витамин Д е свързан с повишена тежест на боледуването от Ковид 19. Листата на доматите съдържат в много ни ски нива един от градивните елементи на ви тамин Д3, наречен провитамин Д3 или 7-де хидрохолестерол (7-DHC). По големи количе ства провитамин Д3, обикновено не се натруп ва в зрелите доматени плодове Изследователи от групата на професор Кати Мартин (Cathie Martin) в Центъра John Innes Centre (разположен в Норич, Норфолк, Англия – б.р.) промениха гена с помощта на тех нологията CRISPR Cas9, за да направят ревизия на генетичния код на доматените растения, така че провитамин Д3 да се натрупва допъл нително в плодовете на доматите. Листата на тези растения съдържат с до 600 микрограма повече провитамин Д3 на грам сухо тегло Пре Генно-редактирани домати – нов източник на витамин Д Домати с редактирани гени произвеждат витаминът на слънцето (витамин
да бъдат
устойчива
за справяне с глобален
в плодовете за производство на молекули и е ус тановено, че определен ензим Sl7-DR2 е отго ворен за превръщането му
се
Те
гени, за да изключат специфична
повишава нивото на провита
Д3 както в плодовете, така и в листата на
растения. При излагане на слънче
Витамин
Д) и могат
проста и
иновация
здравен проблем. поръчителният дневен
в други молекули. Затова изследователите са използвали CRISPR Cas 9, за да изключат този ензим Sl7DR2 в доматите, така че 7-DHC да
натрупва в плодовете на домата.
измерват колко 7-DHC има в листата и плодовете на променените доматени расте ния и установяват значително увеличение на нивата му както в листата, така и в плодовете на обогатените растения 7-DHC се натрупва
а растенията като цяло са много слаби източ

ници Витамин Д3 е най биодостъпната форма на витамин Д и се произвежда в тялото, когато кожата е изложена на слънчева светлина През
рата трябва
или
21 6/22 тенденции както в месестата част, така и в ципата на до матите. След това изследователите тестват дали 7-DHC в обогатените растения може да се пре върне във витамин Д3 чрез осветяване на лис та и нарязани плодове с UVB светлина в про дължение на 1 час. Те установяват, че ефектът е много добър. След третиране с UVB светлина един домат съдържа нива витамин Д еквивалентни на ко личествата в две средно големи яйца или 28 грама риба тон, които са препоръчителни хра нителни източници на витамин Д . Проучването показва още, че витамин Д в зрелите плодове може да се увеличи допълни телно чрез продължително излагане на слън чева светлина по време на процес
на сушене. Блокирането на ензима в доматите няма ефект върху растежа, развитието или добива на домати Методът може да се приложи и при други близки растения, като патладжан, кар тоф и пипер. Тази година правителството на Обединено то кралство направи официално изследване, за да проучи дали храната и напитките трябва да бъдат обогатени с витамин Д , за да се прео долеят проблеми със здравето Повечето храни съдържат малко витамин Д , зимата и в по високите
географски ширини хо
да получават витамин Д чрез диета
добавки, защото слънцето не е достатъчно силно, за да може тялото да произвежда вита мина естествено Друг представител на изследването, д р Джи Ли, казва: Пандемията Ковид-19 помогна да се очертае проблемът с недостатъчните количества на витамин Д и неговото въздействие върху нашата имунна функция и общо здраве. Произведените от нас домати, обогатени с провитамин Д, предлагат много необходимия растителен източник на слънчевия витамин. Това е страхотна новина за хората, които приемат богата на растения, вегетарианска или веганска храна, както и за нарастващия брой хора по света, страдащи от проблема с дефицит на витамин Д. А от Nature Plants твърдят: Биоподсилените домати осигуряват нов път към достатъчни количества витамин Д Оригинална публикация: Biofortified tomatoes provide a new route to vitamin D sufficiency. – https:// www.nature.com/
Доколко са свързани устойчивостта и интелигентните опаковки и какво е бъдещето на партньорствата между тези две области? Андрю Манли, директор комуникации в AIPIA (Active & Intelligent Packaging Industry Association – Асоциация на индустрията за активна и интелигентна опаковка) разяснява: Устойчивост е сложна дума, която отразява още по сложна тема. Определянето на устойчиво развитие като една концепция е малко като да се опитваме да обясним интелигентните опаковки като една технология. Дали двете са съвместими една с друга занимава умовете на специалистите по опаковане, както и на експертите по устойчивост от доста време насам Затова нека да раз гледаме темата.

За протокола: Когато става въпрос за устойчиви опа ковки, терминът обикновено може да означава „по лес ни за рециклиране“, „изработени от възобновяеми или компостируеми ресурси“, „използващи по малко ресур си“ , а сега включва и тенденцията за „повторна употре ба“ вместо за „рециклиране“ По отношение на интели гентните опаковки терминологията се разделя на две общи части, „активни“ и „интелигентни/свързани“ В началото голяма част от елементите на интелигент ните опаковки се считаха за не много щадящи околната среда. Мастилата със сребро и мед, металните етикети с активни покрития, които не са екологични и използва нето на химикали (най често с метални елементи като сребро), които имат антимикробни свойства бяха невъз можни за рециклиране.

22 6/22 опаковки
Интелигентно и устойчиво –могат ли опаковките да бъдат и двете? Според Tetra Pak алуминиевият слой, използван в картонените опаковки за храни, играе критична роля за осигуряване на хранителната безопасност на съ държанието, но допринася за една трета от емисиите на парникови газове, свързани с основните материали, използвани от компанията Заради алуминиевия слой картонените опаковки Tetra Pak се отхвърлят или не се приемат за рециклиране на хартия на някои места, като процентът на рециклиране за тези видове карто нени опаковки е около 20%. От Tetra Pak казват, че първоначално са извършили валидиране на търговска технология за заместване на алуминиевия слой на базата на полимер в Япония, за почвайки в края на 2020 г. 15-месечният процес очевидно е помогнал на ком панията да разбере последиците от преминаването към бариера, базирана на полимер, както и да опреде ли количествено дали решението предлага намаляване на въглеродния отпечатък и да потвърди адекватната защита на зеленчуков сок от кислорода Компанията твърди, че базираната на полимер бариера е насо чена и към увеличаване на нивата на рециклиране в страни, където рециклиращите предпочитат опаковки без алуминий Сега Tetra Pak планира да включи наученото от това изпитване при тестването на нова бариера, базирана на влакна, в тясно сътрудничество с някои от своите клиенти. Джил Тисеран, вицепрезидент в Tetra Pak, коменти ра: Първите резултати предполагат, че опаковката с бариера на базата на влакна ще предложи значително намаляване на CO2 в сравнение с традиционните асептични картонени опаковки, заедно със сравним срок на годност и защита на храните. Вярваме, че това развитие ще действа като пробив в намаляването на въздействието върху климаTetra Pak тества бариера от влакна за опаковки
да
извлечени и рециклирани

удължи срокът на годност или състоянието
, допринасяйки
отношения, също както и мисленето за това какво представлява устойчив и интелигентен път към кръговата икономика И така, в последно време все повече се налага идеята, че повторната употреба може да бъде по ефективна стра тегия от рециклирането. Това се дължи отчасти на проблемите с капацитета за рециклиране (не толкова на нивото на събиране, колко то на възможността да се използват всички материали), а отчасти и поради това, че може да се окаже нерента билно да се рециклира всичко и дори вредно за околна та среда. Според едно изследване на Flexible Packaging Europe (Асоциация на производители на всички видове гъвкави опаковки – б.р.), съществуват ясни доказател ства, че някои гъвкави пластмаси имат по малко въз действие върху околната среда при нулево рециклира не, отколкото твърдите пластмаси при 80% рециклиране Друг е въпросът дали това послание достига до хората. Също така интелигентното опаковане разработи по щадящи околната среда продукти, като хартиени RFID тагове, проводими мастила от рециклируеми материали като графен и активни компоненти на
опаковките, извлечени от естествени източници като це лулоза, растения, етерични масла или дори кожа от ду риан (тропически дървета с големи бодливи плодове –б. пр.) Напоследък се популяризират и цифровите водни знаци и кодове, които могат да помогнат за идентифи цирането и сортирането на различните пластмаси за по ефективно рециклиране По отношение на въздейст вието, интелигентните опаковки могат да допринесат за устойчивото развитие, тъй като способността им да ин формират има потенциал да окаже голямо въздействие. Срещата на върха за устойчиви опаковки на Packaging Europe в Лисабон от 13 до 14 септември т г ще разгледа темите за устойчивата трансформация в опа коването, изискваща промяна на системно ниво и готов ност на всички заинтересовани страни да възприемат нов начин на мислене, както и нови технологии Докато устойчиви срещу интелигентни опаковки е само част от това уравнение, то има определена роля във всеки де бат. Хората искат да рециклират опаковките, но често са объркани как, къде и дори защо. Специалистите по опа ковки могат да разкажат различни истории и да им да дат отговори по прост и достъпен начин. Компании като Tetra Pak и Coca Cola вече са осъзнали това и използват интелигентните технологии за опаковане, за да постиг нат своите цели за устойчивост Със сигурност това все още е работа в процес на развитие на всяко ниво, но със сигурност има място и за много оптимизъм По https://packagingeurope.com/ та. Освен това картонените опаковки с по-високо съдържание на хартия са по-привлекателни за фабриките за хартия; така тази концепция представя ясен потенциал за реализиране на нисковъглеродна кръгова икономика за опаковане. А Ева Густавсон, вицепрезидент по материали и опаковки в Tetra Pak, добавя: Решаването на сложни проблеми като изменението на климата и кръговата икономика изисква трансформационни иновации. Ето защо ние сътрудничим не само с нашите клиенти и доставчици, но и със стартиращи фирми, университети и технологични компании, осигуряващи ни достъп до авангардни компетенции,

23 6/22 опаковки
По
Както при повечето неща, прекаленото опростяване може да доведе до погрешни схващания Отдавна се за стъпва тезата, че рециклирането не трябва да се отнася само до опаковката, а до целия продукт По време на це лия цикъл на производство, храната може да има много по голямо въздействие върху околната среда, отколко то опаковката.
същия начин, има много интелигентни компонен ти при опаковките, които могат
бъдат
и чрез тях да се
на продукта
значител но за неговата устойчивост Освен това технологиите за двата вида опаковки са напреднали в много
евро годишно, за да подобрим още повече екологичния профил на картонените опаковки за храна, включително изследването и разработването на опаковки, които са направени с опростена структура на материала и подобрена възможност за рециклиране. По https://packagingeurope.com/ и и а Националният конкурс ПРИЗ ПАК 2022 очаква Вашата най-добра опаковка... Вашата най-добра идея за опаковка..., за да я награди и покаже на потребителите Подробности на www.fpim-bg.org
технологии и производствени съоръжения. За да поддържаме работата по иновациите, ние инвестираме 100 милиона
Н
атискът върху селскостопанските пазари и енер гийния сектор е масивен, както ни кога досега Производителите на мая са изправени пред две сериозни предизвикателства, които застраша ват безпроблемното извършване на тяхната дейност: от една страна дос тъп до нужните количества от захар на меласа, а от друга – осигуряване на достатъчно енергия за протичане на ферментационните процеси. Макар ситуацията да бе затруд нена още по време на Ковид пан демията, настоящата глобална по литическа обстановка, породена от конфликта между Русия и Украйна, допълнително усложни достъпа до суровини и енергия. Компаниите не само се сблъскват с екстремни увеличения на цените, възможно е дори да се стигне до битка за наличности. Ситуацията е притеснителна! – казва д р Маркус Уок, главен изпълнителен директор на Германската асоциация на произво дителите на мая. – Фокусът на производителите от индустрията е поставен върху осигуряването на количества меласа с приоритет за хранителната индустрия и ферментационните процеси, пред приложението ѝ в други сектори, като производството на био горива.
, което превръща меласа та в бутикова стока на европейския пазар Цените на меласата в момен та се покачват до исторически вър хове, заради недостатъчните коли чества и носят огромни последици, включително риск от ограничаване или спиране на производството. В Италия например има само една захарна фабрика, а добивът на такъв важен ко продукт от чужбина е сложен, заради високите разходи за логистика Най големите произ водители на захар в света са Бра зилия и Индия, които разпределят големи количества меласа за нацио налното производство на биоетанол и по този начин въздействат върху цените на суровините в световен мащаб. Производителите на мая в Гер мания са силно загрижени и заради ограничените доставки на газ: Разглеждайки настоящите събития, очакваме ситуацията да стане още
по-лоша – обяснява д р Маркус Уок. – За ферментационните процеси природният газ е основният енергиен източник. Преминаването към други форми на енергия отнема време, което нямаме сега. А Паоло Гречи, президент на италианските предприемачи в сек тора, подчертава: Наш приоритет са сметките – нашите компании функционират на газ. За съжаление непрекъснатото увеличение на цената на газта и настоящите несигурности относно бъдещите доставки, не само увеличават производствените разходи, но и правят фирменото планиране невъзможно. В допълнение към всичко това е и оскъдната наличност на меласата. Макар и тя да е само остатъчен продукт от преработката на захар, свойствата ѝ са незаменими, защото има силите да „дава живот“ на маята. По интернет


24 6/22 по света
Асо циация на производителите на мас ла и олио ASSITOL също апелират да бъде даден приоритет на храни телната индустрия при усвояване на меласата Основната суровина за произ водство на мая е меласата Този оста тъчен продукт от производството на захар се използва за производство на хлебна мая и фураж за животни. Досегашните доставки за ЕС от Ру сия, Беларус и Украйна, понастоя щем не се извършват или са много
Членовете на италианската
несигурни
Н е д о с т и г н а м е л а с а и Недостиг на меласа и п о с к ъ п в а щ а е н е р г и я – поскъпваща енергия –п р е д и з в и к а т е л с т в о предизвикателство з а п р о и з в о д и т е л и т е за производителите н а м а я на мая
увеличава износа






Селското стопанство е един от воде щите сектори в икономиката на Полша. Това я прави значим производител и износител на селскостопански и храни телни продукти в европейски и свето вен мащаб, както в количествено, така и качествено отношение Само за периода януари – март 2022 година цялостната стойност на износа на селскостопански хранителни стоки от Полша се е увеличил с 16,2% в срав нение със същия период от 2021 годи на на 10,2 милиарда евро Увеличението на износа през пър вите три месеца на 2022 година е глав но в резултат на: плащане на износителите на разликата от обмена на полски злоти/ евро, дължащо се на преобладаващия дял на страните от ЕС в полския износ, което създаде увеличение на годишния доход; конкурентоспособност на цената и на качеството на полските селскостопански хра нителни продукти; дейност на полските предпри емачи за разнооб разяване на бизнес връзките с пазари от трети страни; непрекъс нато търсене на полски продукти на международния па зар благодарение на приспособяване



25 6/22 по света
то на предлаганата продуктова гама към разнообразни те предпочитания на чуждестранните консуматори; относител но малък дял за страните от Общ ността на Независи мите Държави (ОНД) от годишния доход от износа на храни (4,1%),
Полша
на храни (-5%) Структура на полския износ на селскостопански продукти от януари до март 2022 година Месо, месни продукти, живи животни 20% (2,0 млрд. евро) (+28%) Жито и житни продукти 12% (1,2 млрд. евро) (+3%) Тютюн и тютюневи продукти 9% (1,0 млрд. евро (+1%) (+33%) Захар и сладкарски изделия 7% (0,7 млрд. евро) (+17%) Млечни продукти 8% (0,8 млрд.евро) Риба и рибни продукти 6% (0,6 млрд. евро Зеленчуци (вкл. гъби) и техни продукти 5% (0,5 млрд. евро) (+12%) Плодове (вкл. ядки) и техни продукти 4% (0,4 млрд. евро) (+9%) Маслодайни семена, растителни мазнини 3% (0,3 млрд. евро) (+49%) (+10%) Кафе, чай, какао 2% (0,2 млрд. евро) Плодови и зеленчукови сокове 2% (0,2 mld EUR) (+38%) Алкохол 2% (0,2 млрд. евро) (+17%) Други 20% (2,1 млрд. евро) 10,2 млрд. евро
което ограничи негативното влияние на въоръжения конфликт в Украйна върху резул татите от износа на селскостопански продукти като цяло. Около 75% от годишния доход от износ на селскостопански хранителни продукти са от
продажби в страни от Европейския съюз. На ЕС пазара са продадени стоки на стойност от 7,6 милиарда евро, което означава увеличение с 21% в сравнение с първата четвърт от 2021 година. Най-големият годишен доход от износа в 27-те от ЕС е от продажби в Германия (2,6 млрд. евро, увеличение с 18%), Нидерландия (669 млн. евро, увеличение с 34%), Франция (650 млн. евро, увеличение с 26%), Италия (500 млн. евро, намаление с 1%) и Чешката Република (451 млн. евро, увеличение с 25%). Изнесени са селскостопански хранителни продукти на стойност от 2,6 млрд. евро (увеличение с 4%) в страни, които не са членки на ЕС. Важни купувачи на селскостопански хранителни продукти, както и през предишни години, са главно Обединеното Кралство (836 милиона евро, увеличение с 32%), Съединените Щати (183 млн. евро, увеличение с 33%) и Саудитска Арабия (107 млн. евро, намаление с 43%), следвани от Израел (82 млн. евро, увеличение с 29%), Норвегия (69 млн. евро, увеличение с 28%), както и Швейцария (61 млн. евро, увеличение с 38%). През първата четвърт от 2022 година износът към страните от ОНД е на ниво от 416 млн. евро, с 5% по-ниско отколкото през същия период на предишната година. Полша е изнесла в страните от ОНД главно хляб и хлебни продукти (34 млн. евро), шоколадови продукти (26 млн. евро), сирене и извара (21 млн. евро), храна за домашни любимци (19 млн. евро), преработени зеленчуци (16 млн. евро) и пресни ябълки и круши (16 млн. евро). Структурата на стоките от полския износ на храни през първата четвърт на 2022 година е преобладаващо от месо и месни продукти (2,0 млрд. евро, увеличение с 28%), главно месо от домашни птици и говеждо, месни продукти и свинско; жито и житни продукти (1,2 млрд. евро, увеличение с 3%); тютюн и тютюневи продукти (1,0 млрд. евро, увеличение с 1%); млечни продукти (0,8 млрд. евро, увеличение с 33%) и захар и сладкарски захарни изделия (0,7 млрд. евро, увеличение със 17%). Вносът на селскостопански хранителни стоки през първата четвърт на 2022 година възлиза на 7,2 млрд. евро и е с 21,6% повече от предходната година. През периода
история
компанията, ще видите, че Carlsberg
основателят на пивоварната Дж. С. Якобсен винаги са се движили в крак с времето – и дори са го изпреварвали. От откриването на pH скалата до изолирането на чиста развъдна мая в собствената лаборатория за индустриални изследвания на компанията, създадена през 1876 г. А от 2015 г. третата по големина в света пивоварна група работи по поредния иновативен проект: така наречената Fibre Bottle (бутилка от влакна). В момента проектът навлиза в мащабна пилотна фаза под името Fibre Bottle 2.0. В основата на инициативата стои разработването на първата в света бирена бутилка, направена от получени по устойчив път дървесни влакна и PEF (полиетилен фураноат), който вече е (почти) 100% на биологична основа и позволява пълно рециклиране. Новаторският биоразградим слой

26 6 /22 по света
от януари до
положителното търговско
млрд.
съдействие
Посолството
Ако се
на бутилката предлага и допълнително предимство – той изолира бирата и я поддържа охладена за по-продължително време в сравнение с конвенционалните кенове или стъклени бутилки. Д а в а р и ш б и р а з а п о - д о б р о Да вариш бира за по-добро б ъ д е щ е бъдеще Във фазата на проекта в момента новите Fibre Bottles за първи път достигат до избрани отраслови играчи в цяла Европа. Тези найактуални прототипи съдържат бира, сварена с биологично отгледан регенеративен ечеП о с л е д н а т а Последната в е р с и я версия б у т и л к а бутилка о т в л а к н а от влакна н а на C a r l s b e r g Carlsberg
март 2022 година
салдо възлиза на 3,0
евро, което е с 5,1% по-високо от съответния период през 2021 година. инж. Мая Гелева По сп. Polish Food/ лято 2022 г. Статията се публикува с любезното
на
на Полша в София
вгледате в 175-те години
на
и
мик, като фокусът е върху холистичния прогрес на революционните технологии и устойчивите практики в пивоварната индустрия. На осемте западноевропейски пазара – Германия, Дания, Швеция, Норвегия, Финландия, Великобритания, Полша и Франция ще бъдат тествани общо 8 000 Fibre Bottles, като в хода на пилотния проект ще бъде генерирана обратна връзка от ангажираните заинтересовани страни. Изпитанията с подобен мащаб позволяват да се съберат впечатления от опита на хората с продукта, които ще залегнат в разработката на следващото поколение на дизайна. Н о в а т а F i b r e B o t t l e в п р я г а Новата Fibre Bottle впряга п о т е н ц
PEF Докато външната част на прототипите, дело на компанията за опаковки Paboco, е направена от устойчиво получени и подлежащи на пълно рециклиране дървесни влакна, за вътрешното покритие на бутилките е използван тънък пластмасов филм, направен от 100% био-базиран полимер PEF (полиетилен фураноат), който гарантира свежестта на съдържанието на амбалажа. Разработеният от водещите експерти в сферата на възобновяемата химия Avantium продукт PEF е произведен изцяло от естествени суровини. Той е съвместим със системите за рециклиране на пластмаси и подлежи на разграждане в природата в случай, че остане извън националните рециклиращи системи. В допълнение към предимствата на устойчивите опаковки, PEF действа и като високоефективна бариера между бирата и външния корпус на бутилката, запазвайки по този начин аромата и карбонизацията на бирата значително по-добре, отколкото традиционните PET пластмаси. Настоящото поколение 2.0 на Fibre Bottle вече се представя по-добре от стъклената бутилка за еднократна употреба в контекста на екологичния баланс на продукта, като генерира до 80% по-малко емисии. Това означава, че за същия въглероден отпечатък, който оставя производството на една-единствена стъклена бутилка за еднократна употреба,

на устойчивостта иновации не се ограничават единствено до бутилката, а намират отражение и върху нейното съдържание: в сътрудничество с доставчика на ечемичен малц Soufflet бирата, сварена за целите на пилотната фаза, е направена от ечемик, отгледан по изцяло биологичен метод. Това не само подобрява биоразнообразието на полето, но стимулира почвеното здраве и увеличава естественото секвестиране на въглерод в почвата в сравнение с конвенционалните земеделски практики. Целта е към момента на пазарна готовност да бъде постигнат въглероден отпечатък, идентичен на този от стъклената бутилка за многократна употреба, която в момента е най-добре представящата се първична опаковка, ако бъде включена в ефективни системи за събиране и повторно пълнене. Очакванията са масовото внедряване на Fibre Bottle да доведе до разширяване обхвата на използваните опаковки в отговор на променящото се търсене и да допълни наличните алтернативи – стъклените бутилки и кеновете. По https://www.yumda.com/
бутилки, Carlsberg вече проучва алтернативни капачки на основата на влакна, като широко приложимо решение на проблема се очаква през 2023 г.
„Д-р Грозева - Аромс а“ ЕООД - Аромса“ Нашата мисия Да откликнем на търсенето на аромати и вкус за хранителната индустрия... Нашата визия Като водещ производител на аромати Аромса реализира и се адаптира към промените в хранителния сектор, благодарение на своето творчество, богата култура и новаторство... Пловдив, ул. „Младежка“ 40 тел./факс: 032/ 64 62 85; 032/ 64 62 86; GSM: 088/7629411 e-mail:boiang@abv.bg; web site: www.aromsa.net

27 6/22
по света
и а л а н а P
потенциала
пет Fibre Bottles от типа 2.0. Б л и з о с т о п р о ц е н т о в а Близо стопроцентова в ъ з м о ж н о с т з а р е ц и к л и р а н е възможност за рециклиране Единственото изключение от комплексния цикъл на рециклиране на Fibre Bottle е капачката на бутилката, която осигурява качеството на нейното съдържание. Заедно с опаковъчната компания Paboco и други партньори от сектора на картонените
С в а р е н а с н е к о н в е н ц и о н а л е н Сварена с
е ч е м и к ечемик Подчинените
E F
на
могат да бъдат направени
неконвенционален
Шведската компания за полезни снаксове Nick’s си партнира с диджея и музикален продуцент Zedd при лансирането на лимитиран сладолед. Chilly Mango съчетава сладолед от манго, подправки и ягоди. Новото предложение, подходящо за следващите кето диета, няма добавена захар и съдържа 9 грама протеин и 240 калории на пинта (1 пинта (UK) = 0,5683 литра). Главният изпълнителен директор на Nick’s Карлос Алтшул коментира: „Партньорството ни със Zedd беше изключително жизнено, което намери отражение в уникалния и автентично авантюристичен вкус на Chilly Mango, освежаващ сладолед от манго с перфектното количество подправки и нотки на сладки ягоди.“



да могат да избират продукт, който е по-близък до техните хранителни навици. В тази светлина гръцката компания за безалкохолни напитки EPSA току-що пусна нова продуктова линия, наречена zer0 (нула), състояща се от 3 вкуса: лимонада zer0, газиран портокал zer0 и EPSA Кола zer0. Според фирмата новите безалкохолни напитки съчетават отличителния, много обичан вкус на EPSA в нискокалорична версия, като същевременно са освежаващи и вкусни. Новите продукти се предлагат в две различни опаковки (330ml кен и 1,5L PET бутилки) и вече са налични на пазара. EPSA е гръцка компания за безалкохолни напитки и освежителни напитки, основана през 1924 г. и разположена в географския район на Пелион (Централна Гърция).
Британският сладоледен бранд Jude’s обединява усилията си с производителя на ментов шоколад Summerdown в производството на нов веган сладолед – Jude’s Plant Based Mint Chocolate. Новият ментов шоколадов сладолед има кадифена шоколадова текстура, обогатена с парченца тъмен шоколад. В направата му се използва добивана и дестилирана от Summerdown мента English Black Mitcham. Управляващият директор Чоу Мезгер коментира: В процеса на създаването на този великолепно балансиран ментов шоколадов сладолед за нас беше абсолютна наслада да се възползваме от експертизата
28 6 /22
През последното десетилетие продуктите с нулева захар са силна тенденция и все поголям брой марки предлагат опции без захар, като се има предвид необходимостта на
Нови безалкохолни напитки с нулева захар Ментов шоколадов
Лимитирано издание сладолед новости
на хората в Summerdown. Новият сладолед е невероятно нежен и аз обожавам начина, по който този продукт съчетава сладоледа, шоколадовия вкус и хрупкавия шоколадов чипс. https://www.foodbev.com/
потребителите
сладолед на растителна основа
по винарство на Университета по хранителни технологии (УХТ) в Пловдив. С това решение постави УХТ на световната карта на престижните академични винарски центрове наред с Националния висш институт по аграрни науки в Монпелие (Франция) и Калифорнийския университет в Дейвис (САЩ). В писмото си генералният директор на OIV Пау Рока заявява: „Осигуряването на обучение на квалифицирани специалисти във винарския сектор в съответствие с международно приетите стандарти без съмнение е ключ към успеха за страна, която се стреми да играе важна роля на международния пазар на вино“. Програмата “Technology of Wine and WineBased Beverages” e разработена като пилотен проект в рамките на инициативата на международната организация за хармонизиране на университетското обучение по енология. УХТ е избран на базата на почти 70-годишната си традиция и доказана експертиза в обучението на студенти, включително чуждестранни, в областта на технологията на виното и високоалкохолните напитки. Освен това, той е единственият български и един от двата балкански университета, членуващи в Международната






В рамките на срещата се обсъдиха дейностите на проекта, свързани с разработването на учебен план за висше образование в образователно-квалификационната степен „магистър“, включващ 10 курса по интердисциплинарната тема за „Ресурсната ефективност в производствените индустрии и цялостната системна оптимизация.“ Коментирани бяха нормативните изисквания на всяка от страните партньори относно обученията по програми, извеждани от няколко университета и изискванията за получаване на диплома от повече от един университет. Според координатора на проекта, доц. д-р Таня Титова –декан на Технически факултет при УХТ-Пловдив, срещата е изиграла важна роля за изграждане на устойчиво партньорство. Създадените учебни програми са изцяло съобразени с изискванията на бързо развиващата се индустрия в Тракия икономическа зона. УХТ като член на „Клъстер Тракия икономическа зона“ развива връзката бизнес – образование за създаването на нужните квалифицирани кадри. По https://uft-plovdiv.bg/

чужбина.
координираща
сътрудничество в областта на лозарството и винарството, в която членуват 48 държави от цял свят, включително и България.
МАШИНИ ЗА ПРЕРАБОТКА , СОРТИРАНЕ И ПАКЕТИРАНЕ НА ЗЕЛЕНЧУЦИ И ПЛОДОВЕ Машини произход Китай, Сертификат СЕ, сервиз, поддръжка и резервни части www.sanmax.info +359876989710 +3592 444 4902 У Х Т в т о п 3 н а в и н а р с к и т е УХТ в топ 3 на винарските у н и в е р с и т е т и в с в е т а университети в света Международната организация по лозата и виното (OIV) официално одобри новата магистърска програма
асоциация на винарските университети. Одобрението на OIV за магистърската програма се отнася за тригодишен пилотен проект. Обучението ще се извършва на английски език, като вече има изразен интерес за участие в програмата и
вести от УХТ
на партньорски университети от страната и
OIV е междуправителствена организация,
научно-техническото
В Офенбург, Германия, се проведе първата международна партньорска среща по проект „Ресурсната ефективност в производствените индустрии и цялостната системна оптимизация“ (EREMI), №2020-1-BG01-KA203-079076, в която взеха участие партньори от четири държави (България, Румъния, Северна Македония, Германия): 4 университета, предлагащи инженерно обучение (Университет по хранителни технологии – Пловдив, University Politehnica of Bucharest, University “St. Kliment Ohridski“ – Bitola, University of Applied Sciences Offenburg и BEIA Consult International (Румъния), партньор на Siemens, извършващ научно-изследователска и развойна дейност и водещ доставчик на ICТ решения и услуги в Румъния. П л о в д и в , Б у к у р е щ , О ф е н б у р г и Б и т о л я Пловдив, Букурещ, Офенбург и Битоля с ъ з д а в а т у ч е б е н п л а н з а м а г и с т р и създават учебен план за магистри
е Резюме Проведени са ферментационни опити с горноферментиращ щам пивни дрожди и пивна мъст, обогатена с псевдо-зърнена култура (амарант) и ядливи цветя (глухарче и невен), с цел получаване на пиво тип ейл с подобрени антиоксидантни качества. Обогатяването с растителни добавки подобрява усвояването на α-аминен азот от дрождите. Горчивината не се влияе значително от наличието на растителни добавки. Добавянето на псевдо-зърнена култура и ядливи цветя води до слабо повишаване на рН на готовото пиво. Ядливите цветя са добър източник на полифеноли. При пивата, съдържащи невен и глухарче, този показател дава повишение спрямо контролата. Съдържанието на флавоноиди в пивото не се повишава при обогатяването на мъстта с растителни добавки. Слабо повишение на антоцианогените се наблюдава при трите варианта с добавки. Повишение на антиоксидантната активност се отчита при пивата, съдържащи цветя. Получените пива са светли, с чист вкус и аромат, с хармонична горчивина. Пивата, обогатени с амарант, са по-мътни спрямо контролата, съдържаща 100% ечемичен малц.
Ключови думи: антиоксидантна активност, полифеноли, антоцианогени, флавоноиди, ферментация, пивни дрожди, амарант, глухарче, невен
Antioxydant activity of ale type beer with added amaranth and eadible flowers
s.as. PhD Iva Tomova, s. expert Albena Mitreva, s. expert Yolina Dacheva Institute of Cryobiology and Food Technologies, Agricultural Academy, Sofia 1407, 53, Cherni vrah blvd.; e-mail: tomova_iva@abv.bg;
A b s t ra c t bstract
Fermentation experiments with top-fermenting brewing yeast strain were carried out with wort enriched with pseudo-cereals (amaranth) and edible flowers (dandelion and calendula), in order to obtain ale type beer with improved antioxydant qualities.

Enrichment with plant supplements improved absorption of α-amine nitrogen by yeasts. The bitterness was not significantly affected by the presence of herbal supplements. The addition of pseudo-cereals and edible flowers led to a slight increase in the pH of the finished beer.
Edible flowers are a good source of polyphenols. For beers containing calendula and dandelion, this indicator showed an increase compared to the control.
The content of flavonoids in beer did not increase when the must was enriched with plant supplements. A slight increase in anthocyanogens was observed in all three variants with additives. Increase in antioxidant activity was observed for flower containing beers.
The resulting beers were light, with pure taste and aroma, with harmonious bitterness. Beers enriched with amaranth were cloudier than the control containing 100% barley malt.
Keywords: antioxidant activity, polyphenols, antocyanins, flavonoids, fermentation, brewing yeasts, amaranth, dandelion, calendula
Buiatti,

Хранително-вкусова
30 6/22 храни и наука Р
промишленост
е з ю м
В ъ в е д е н и е Въведение Ейлът е тип пиво, популярно главно в Британия, Германия, Канада, Белгия и САЩ (Pavsler and
2009); получава се чрез горна ферментация при 1520°C с дрожди Saccharomyces сerevisiae. Горната ферментация е
в сравнение с
се получава пиво тип лагер.
образуват пяна на повърхността на ферментиращата мъст, откъдето Антиоксидантна активност на пиво тип ейл с добавени амарант и ядливи цветя гл. ас. д-р Ива Томова, ст. експерт Албена Митрева, ст. експерт Йолина Дачева
ускорена
долната, при която
Дрождите
произлиза названието на процеса. В исторически аспект, S. cerevisiae се считат за „оригиналните“ пивни дрожди, използвани за производство на най-древните видове пиво по времето на Вавилония. Те имат повишена алкохолна толерантност, поради което продуцират пива с по-високо алкохолно съдържание (Eckhardt, 2008). Ферментацията с тези дрожди при относително високи температури води до получаване на пиво с повишено съдържание на естери. Във връзка с това ейлът се характеризира с по-висока плътност, плодов вкус и засилен аромат спрямо лагера. За разлика от лагера, който се консумира силно охладен, за ейла е препоръчителна по-висока температура (7-11°С). Отлежаването на ейла трае от няколко дни до месеци. Вариантите на пиво тип ейл са изключително разнообразни: английски, шотландски, ирландски, американски, индийски, германски, белгийски, френски ейл, портър, стаут и т.н., като всеки от тях има свои разновидности. Наблюдават се значителни вариации на цвета, алкохолното съдържание, суровините, съдържанието на естери, аромата, вкуса. Ра с т и т е л н и д о б а в к и
Растителни добавки Всички зърнени култури са едносемеделни растения от сем. Житни (Poaceae). За разлика от тях, псевдо-зърнените култури не са близкородствени помежду си и със зърнените, но, подобно на последните, образуват сухи скорбелни семена. Псевдо-зърнените култури са двусемеделни растения, принадлежащи към различни семейства. Те не са чувствителни към заболяванията, от които страдат житните растения, и са по-малко взискателни към условията на култивиране. Някои псевдо-зърнени култури са включени в категорията на т. нар. „функционални храни“ (в последните години се налага терминът „суперхрани“), тъй като имат балансиран хранителен състав и ценни качества. Амарант (Amaranthus). Причислява се към т.нар. „суперхрани“; хранителният му профил превъзхожда този на ечемика, елдата, просото (Weerasekara and Waisundara, 2020). Не съдържа глутен (Gallagher et al., 2004); богат е на диетични влакнини (Venskutonis and Kraujalis, 2013). Предимството му пред традиционните зърнени храни е относително високото белтъчно съдържание и по-балансиран състав на незаменимите аминокиселини (Andrasofszky et al., 1998). Присъстват ω-3, ω-6 и ω-9 мастни киселини (Schoenlechner et al., 2008). Съгласно Murakami et al. (2014), амарантът има балансиран витаминен състав, съдържа необходимите концентрации от всички макро- и повечето микроелементи, които са нужни за човешкото хранене. Амарантът съдържа съединения с антиоксидантна активност: токофероли и токотриеноли (Niro et al., 2019), пигменти (каротиноиди, антоцианини, беталаини, бетаксантини и др.), флавоноиди (рутин, кверцетин, витексин и др.), фенолни киселини (Sarker et al., 2018а,b,c; Niro et al., 2019), фитостероли (Marcone et al., 2003). От растението са изолирани биоактивни пептиди, напр. – лунасин (с антиканцерогенни свойства –Silva-Sánchez et al., 2008); богат на пролин пептид с антибактериални свойства (Moyer et al., 2019). Амарантът е хранителен източник за вегетарианци (Sarker et al., 2015), понижава LDL холестерола, повлиява имунната система, нивата на глюкоза в кръвта, функциите на черния дроб, въздейства благоприятно на страдащи от цьолиакия (Caselato-Sousa and Amaya-
Farfán, 2012), има антианемичен (Das, 2016), диуретичен (Grubben and Denton, 2004) и противовъзпалителен ефект (Montoya-Rodríguez et al., 2014). Маслото от амарант се прилага при повишено кръвно налягане, коронарна болест на сърцето (Martirosyan et al., 2007). Обикновеното глухарче (Taraxacum officinale) има антиоксидантни свойства, свързани с наличието на биологично активни вещества: флавоноиди (лутеолин, мирицетин, хесперидин, витексин и др. –González-Castejón et al., 2014; Srividya et al., 2008), каротиноиди и антоцианини (Gomez et al., 2018), полизахариди и тритерпени (Wirngo et al., 2016). Глухарчето съдържа ω-3, ω-6 и ω-9 мастни киселини, както и наситени мастни киселини (Díaz et al., 2018), диетични влакнини (Escudero et al., 2003); богато е на цикориева киселина (Ivanov, 2015), която инхибира HIV интегразата. Съгласно Hudec et al. (2007) и Bruneton (1995), глухарчето съдържа повече β-каротен от морковите и повече желязо и калций от спанака. Цветето редуцира нивата на триглицеридите (González-Castejón et al., 2014), прилага се при диабет тип 2 (Wirngo et al, 2016), заболявания на черния дроб и панкреаса (Domitrović et al., 2010), сърдечно-съдови болести, понижава LDL холестерола (Choi et al., 2010), има противовъзпалитени свойства (Xiong et al., 2014). Oт него са изолирани антимикробни пептиди (Astafieva et al., 2013). Екстрактът от глухарче има антитуморни и имуномодулиращи свойства (Tumbarski et al., 2016). Растението се употребява в кулинарията – цветовете и листата се добавят в салати, а корените служат като заместител на кафето (Sweeney et al., 2005). Лечебният невен (Calendula officinalis) се прилага в медицината, парфюмерията, кулинарията (напр. като заместител на шафрана). Използва се за борба с оксидативния стрес (Sabir et al., 2015); съдържа флавоноиди – кверцетин, рутин, изорамнетин и др. (Fonseca et al., 2010). Отличава се с голямо разнообразие от каротиноиди. Сортовете с жълти цветове са богати на ксантофили, а оранжевите съдържат по-големи количества въглеводороди (Petri and Lemberkovics, 1994). Невенът е източник на багрила (Qazi et al., 2016). Етеричното масло, извличано от растението, съдържа над 40 моно- и сескитерпени (Naguib et al., 2005). Преобладаващата полиненаситена мастна киселина е календовата киселина; следват линолова (ω-6), олеинова (ω-9), палмитинова киселина. Установено е наличие на антоцианини (Qazi et al., 2016), кондензирани танини (Deuschle et al., 2015), стероли (Alsoufi et al., 2019). Цветето има хиполипидемичен ефект (Chakraborthy et al., 2011), кардиопротективни свойства, понижава кръвното налягане и холестерола (Ray et al., 2010); противовъзпалително и хепатопротективно действие; предпазва от диабет, подобрява кръвообращението, освен това е отлично средство за детоксикация (Mishra et al., 2012). Установени са антиалергични (Schneider et al., 2015), антибактериални (Pintea et al., 2003) и противогъбични свойства (Kasiram et al., 2000). Стимулира имунната система, притежава антитуморно действие (Jiménez-Medina et al., 2006). Екстрактът от цвят на невен инхибира ензима HIV-1 обратна транскриптаза (Kalvatchev et al., 1997). Целта на настоящата разработка е да се изследват антиоксидантните свойства на пиво тип ейл, получено от пивна мъст, обогатена с амарант и ядливи цветя.
Хранително-вкусова промишленост 31
6/22 храни и наука
и методи Пивна мъст: За ферментацията е използвана пивна мъст, получена по инфузионен метод на майш-апарат Bender & Hobein. Контролният вариант пивна мъст съдържа 100% ечемичен малц. При трите останали варианта 20% от ечемичния малц е заменен с немалцуван амарант. Хидромодулът на смесване е 1:3. Работено е с 5 температурните паузи в границите от 40ºС до 70ºС за 120 минути. Варенето на мъстта е извършено на Келдалов апарат (90 минути). Oхмеляването (90 mg/l α-киселини) е проведено на две партиди: I партида – горчив сорт Galena – 70%, добавен 10 min след началото на варенето; II партида – ароматни сортове Perla – 15% и Hallertau Mittelfrueh – 15%, 30 min след началото на варенето. Два от вариантите с амарант съдържат и цветя (невен и глухарче). Цветята (като сухи субстанции) са добавени в концентрация 8,5 g/l, 30 min преди края на варенето. След края на варенето са отстранени горещите утайки, след което мъстта е охладена. Щам: Използван е горноферментиращ щам 2 (Bry97 West Coast Ale Yeast). За получаване на необходимото количество биомаса, дрождите са култивирани в пивна мъст, стационарно, като периодично е добавяна свежа мъст за обогатяване на средата. Клетките са реколтирани чрез центрофугиране. Постановка на опитите: Проведени са опити според методика на Европейската пивоварна конвенция (ЕВС) (Analytica Microbiologyca EBC, 2001), във ферментационни тръби с обем 0,5 l, при 15ºС. Посевното количество клетки е 18-19.106/ml. След провеждане на главната ферментация пивото отлежава 14 дни при 2-4°С.
Табл. 1. Физико химични показатели
на охмелена пивна мъст
,
тели
храни и наука М а т е р и а л и и м е т о д и Материали
Хранително-вкусова промишленост 32 6/22
Р е з ул т а т и и Резултати и о б с ъ ж д а н е обсъждане В Табл. 1 са представени физико-химичните показа-
на четирите варианта
от
Табл. 2. Ферментация с пивна мъст, съдържаща амарант и ядливи цветя –параметри
проследени в динамика Час 100% ечемичен малц (контрола)20% амарант Брой клетки/ ml.106 Екстракт, масови % рН Пъпкуващи клетки, % Брой
Час 20% амарант и 8,5 g/l невен20% амарант и 8,5 g/l глухарче Брой клетки/ ml.106 Екстракт, масови % рН Пъпкуващи клетки, % Брой клетки/
Екстракт,
Пъпкуващи клетки,
Анализи: По време на ферментацията са проследени следните основни показатели: развитие на размножителния процес (съдържание на пъпкуващи клетки и общ брой клетки); скорост и степен на ферментация (усвояване на екстракта на пивната мъст); промяна на рН. Пивната мъст и готовото пиво са анализирани по основни физико-химични показатели (екстракт, рН, цвят, горчивина, полифеноли, антоцианогени, флавоноиди, α-аминен азот) съгласно методи на ЕВС (Analytica EBC, 1998), а радикалулавящата способност (чрез DPPH-метод) по модифициран метод на Маринова-Бъчваров (2011).
пивна мъст, използвани при експеримента. Най-висок е екстрактът на мъстта при контролата –10,71%; замяната на част от ечемичния малц с амарант понижава екстракта. Растителните добавки водят до слабо повишаване на рН. Замяната на 20% от ечемика с амарант води до слабо понижение на съдържанието на α-аминен азот спрямо варианта със 100% ечемичен малц. При вариантите, съдържащи цветя, стойностите са съпоставими с тази при контролата. При варианта с 20% амарант не се отчита увеличено съдържание на полифеноли спрямо контролата, но добавянето на ядливи цветя повишава значително този показател (увеличението е 1,27 пъти при невена и 1,41 пъти при глухарчето). Обогатяването на мъстта с растителни добавки не води до значителна промяна на горчивината, не се отчита и повишено съдържание на флавоноиди. Развитието на щама протича по идентичен начин за всички варианти, като на 24-тия час най-нисък е броят на клетките при контролата, а най-висок – при 20%
100% ечемичен малц (контрола), 20% амарант; 20% ама рант и 8,5 g/l невен; 20% амарант и 8,5 g/l глухарче Показатели 100% ечемичен малц (контрола) 20% амарант 20% амарант и 8,5 g/l невен 20% амарант и 8,5 g/l глухарче Eкстракт, масови %10,7110,5810,6310,64 рН5,725,905,905,90 Цвят, ед.
ЕBC15,119,523,427,5 Горчивина, ГЕ29,628,729,329,8 α-аминен азот, mg/l174166175172 Полифеноли, mg/l306,3300,4389,4431,4 Флавоноиди, mg/l22,819,117,418,4
клетки/ ml.106 Екстракт, масови % рН Пъпкуващи клетки, % 01810,715,72-1910,585,9024486,545,0033536,314,9235 48664,434,4341644,004,4542 72533,274,5030543,644,6334 96341,854,6024413,124,6525 Край121,764,675152,664,686
ml.106
масови % рН
% 01810,635,90-1810,645,9024495,845,1133515,704,9236 48703,984,5947673,734,6042 72533,854,7135513,514,7236 96393,714,8226423,304,7625 Край133,674,823163,124,766
амарант; около 1/3 от клетките са пъпкуващи. През следващото денонощие развитието на дрождите достига пика си, като най-висок е броят на суспендираните клетки при вариантите, съдържащи цветя. Пъпкуващите клетки са почти 1/2 от общия брой при варианта с невен; при останалите варианти са малко над 40%. След 48-мия час започва плавно утаяване на клетките. На 72-рия час броят на суспендираните клетки във ферментиращата мъст е 51-54.106 кл/мл (по-рязко е спадането при вариантите с цветя). Пъпкуващите дрожди са около 1/3 от общия брой. При 20% амарант и при невена се наблюдава изразена утайка, докато при контролата и глухарчето тя е по-незначителна. На 96тия час утаяването продължава, пъпкуващите са около 1/4 от общия брой. Утайката при 20% амарант и при невена е най-значителна, докато при останалите два варианта тя е по-слабо изразена. В края на ферментацията най-нисък е броят на неутаените клетки при контролата, а най-висок – при глухарчето. Изходният екстракт на мъстта е от 10,71% при контролата до 10,58% при 20% амарант; при вариантите с цветя стойностите са идентични (10,63-10,64%). В началото на процеса, във връзка с бързото размножаване на дрождите, се наблюдава рязък спад (с 4-5%); изчерпването на екстракта е ускорено при мъстта, съдържаща ядливи цветя. На 24-тия час стойностите при вариантите с невен и глухарче се отчита най-резкият спад в хода на експеримента. На 48-мия час остатъчният екстракт е 35% при глухарчето и 37% при невена; сходна е стойността и при 20% амарант – 38%, докато при контролата усвояването е по-бавно (остатъчният екстракт е 41% от изходния). След 48-мия час изчерпването на екстракта се забавя (във връзка със започващото утаяване на дрождите). На 72-рия час остатъчният екстракт е около 1/3 от изходния при всички варианти. В заключителния етап от процеса изчерпването на екстракта е забавено при вариантите с растителни добавки. Контролата се отличава от последните, тъй като при нея понижението на екстракта в последните часове от главната ферментация е позначително. На 96-тия час остатъчният екстракт при 100% ечемичен малц е 17%; при останалите варианти (20% амарант, амарант и невен, амарант и глухарче) стойностите са съответно 30%, 35% и 31%. В края на процеса остатъчният екстракт показва значителни разлики при четирите опитни варианта. Най-ниска е стойността при контролата - 16%. При трите варианта с растителни добавки най-пълно изчерпване на изходния екстракт се отчита при 20% амарант (остатъчният екстракт е 25%). При глухарчето стойността е 29%, а най-значителна част от изходния екстракт остава неферментиран при невена - остатъчният екстракт в края на ферментацията е 34%. Изходното рН на контролната пивна мъст е 5,72; прибавянето на растителни добавки води до слабо повишение, като стойността за трите варианта (с ама-
рант, невен и глухарче) е идентична – 5,90. Подобно на екстракта, най-рязък спад на рН е отчетен на 24-тия час. При два от вариантите спадът е с цяла единица. Най-ниско рН се отчита на 48-мия час, като стойностите са почти идентични за контролата и 20% амарант (4.43-4,45) и за вариантите с невен и глухарче (4,594,60). От този момент нататък се наблюдава бавно алкализиране на ферментиращата мъст, свързано със започващия лизис на дрождите. През следващите две денонощия рН на всички проби се покачва плавно; на 96-тия час стойностите при вариантите с цветята са малко по-високи, отколкото при контролата и 20% амарант. До края на процеса не се отчита промяна на рН при опитните варианти с невен и глухарче; при другите две проби стойностите остават по-ниски, като почти се изравняват. След приключване на главната ферментация са проведени анализи на получените варианти младо пиво. Резултатите са обобщени в Табл. 3.
химични и микробиологични показатели на младо пиво ПоказателиКонтрола 20% амарант 20% амарант и 8,5 g/l невен
20% амарант и 8,5 g/l глухарче Начален екстракт, масови %10,5410,5610,2210,52 Привиден екстракт, масови %1,762,663,673,12 Действителен екстракт, масови % 3,434,164,914,53 Алкохол, масови %3,643,282,713,07 рН 4,674,684,824,76 α-аминен азот - остатъчен, mg/l - усвоен, % 72 58,62 57 65,66 65 62,86 58 66,28 АР-тест (ферментационна активност) 2,662,602,632,69 Прираст биомаса, пъти2,171,841,821,73 Мъртви клетки, %12101011
Привидният екстракт в края на ферментацията се колебае в широки граници, което налага извода, че ферментирането на изходния екстракт зависи в значителна степен от състава на пивната мъст. Стойността е най-ниска при контролата, което предполага, че класическата пивна мъст, съдържаща 100% ечемичен малц, се ферментира най-пълно от избрания щам. Най-висока е стойността при 20% амарант и невен (най-значителна част от изходния екстракт остава неферментиран). Подобно на привидния екстракт, действителният екстракт е най-нисък при контролата – 3,43%. При останалите варианти стойността му е над 4%, като отново е най-висока при 20% амарант и невен. Алкохолното съдържание на младото пиво е найвисоко при 100% ечемичен малц – 3,64%. При заместване на 20% от ечемика с амарант стойността се понижава до 3,28%, а добавянето на цветя понижава още повече
Хранително-вкусова промишленост 33
6/22 храни и наука
на пивото. рН в края на ферментацията е почти идентично при контролата и 20% амарант. Добавянето на ядливи цветя
до
повишение на стойностите на рН за младото пиво. При всички опитни варианти се отчита над
Табл. 3. Физико
алкохолното съдържание
води
леко
50%
усвояване на α-аминния азот, съдържащ се в мъстта. Най-пълно е усвояването при наличие на амарант и глухарче в мъстта; при 20% амарант стойността е малко по-ниска. Единствено при контролния вариант стойността е малко под 60%, което предполага, че прибавянето на растителни добавки в мъстта подобрява усвояването на α-аминния азот от дрождите. Резултатите от АР-теста варират в тесни граници и доказват добрата ферментационна способност на избрания щам. Най-ниска е стойността при варианта с 20% амарант, а най-висока – при 20% амарант и глухарче. Прирастът на биомаса е най-висок при контролата – малко над 2 пъти. Наличието на растителни добавки в мъстта води до слабо понижение на този показател. При вариантите с 20% амарант и 20% амарант и невен стойностите са почти идентични – около 1,8 пъти, а при варианта с амарант и глухарче – 1,7 пъти. Щамът показва добра жизнеспособност, като съдържанието на мъртви клетки е 10-12% (най-високо е при контролата). Резултатите от анализите на готовото пиво са обобщени в Табл. 4. Привидният екстракт показва слабо понижение след отлежаването. Най-нисък привиден екстракт (съответно – най-пълно ферментиране на изходния екстракт) се отчита при контролата. При трите опитни варианта с растителни добавки стойностите са по-високи; подобно на резултатите за младото пиво, най-висок остава привидният екстракт при пробата с амарант и невен (при нея се отчита и най-ниска привидна ферментационна степен). Същата тенденция се наблюдава и за действителния екстракт. Съгласно Kordialik-Bogacka et al. (2018), добавянето на амарант подобрява съотношението Mg2+/Ca2+, необходимо за ефективна трансформация на захарите до етанол, както и съдържанието на Zn2+ и Mg2+, дори когато само 10% от ечемичния малц е заменен с псевдо-зърнената култура. Резултатите от настоящите
експерименти показват, че алкохолното съдържание на пивото с 20% амарант е повишено спрямо вариантите с добавени ядливи цветя. Единствено при контролата се отчита по-високо алкохолно съдържание, което обаче е свързано с факта, че при нея се наблюдава преферментиране (ПФС е почти 84%, докато при 20% амарант стойността е 75%). Най-ниско е алкохолното съдържание на пивото, съдържащо невен (пробата, при която и най-голяма част от изходния екстракт остава неферментиран). Отлежаването не повлиява рН, като стойностите остават почти идентични с тези, измерени в края на ферментацията. Прибавянето на растителни добавки води до слабо повишение на рН спрямо контролата, което е най-значително при наличие на невен в мъстта. Стойностите при пивата с цветя са малко по-високи, отколкото при варианта с амарант. Количеството усвоен α-аминен азот се повишава слабо след отлежаването и надхвърля 60% при всички варианти. Най-добро усвояване на α-аминния азот е установено при наличие на глухарче в мъстта; сравнително близка е и стойността при варианта с амарант. Подобно на резултатите за младото пиво, най-ниско остава количеството усвоен азот при контролния вариант. Горчивината на готовото пиво е сходна при всички опитни варианти, т.е. – добавянето на псевдо-зърнената култура и ядливите цветя към мъстта не оказва значително влияние върху този показател. Известно е, че в състава на цветята присъстват горчиви вещества (Arora et al., 2013; Josephson et al., 2016), но добавянето им към мъстта не влияе върху количеството на изохумулоните и съответно – върху горчивината, измерена по методиката на EBC (Analytica EBC, 1998). Съдържанието на полифеноли в контролата е 287,9 mg/l. При варианта с амарант стойността е сходна с контролната, а при наличие на ядливи цветя се отчита значително повишение – 27,6% при варианта с невен и 38,8% при глухарчето. Количеството флавоноиди в контролата е малко над 21 mg/l. Добавянето на амарант и цветя не допринася за обогатяване на пивото с флавоноиди. Антоцианогените в контролата са 90,5 mg/l; при останалите три опитни варианта стойностите показват слабо повишение (от 0,9% при пивото с амарант до 3,2% при глухарчето). Обогатяването на мъстта с растителни добавки допринася за повишаване (в ниска степен) на съдържанието на антоцианогени в пивото. Антиоксидантната активност, изразена като екв. вит. С mmol/l, е идентична при контролата и варинта с 20% амарант. При опитните варианти с ядливи цветя се отчита повишение – 22,9% при
Действителен екстракт, масови % 3,374,124,844,41 Алкохол, масови %3,663,312,823,16 ПФС, %83,9275,3465,7171,96 ДФС, %67,9961,0553,2358,28 рН 4,664,704,834,76 Цвят, eд. EBC811,718,121,7 Горчивина, ГЕ22,621,922,322,5 α-аминен азот - остатъчен, mg/l - усвоен, % 68,3 60,75 54,9 66,93 62 64,57 55,6 67,67 Полифеноли, mg/l287,9283,5367,4399,7 Флавоноиди, mg/l21,418,416,417,8 Антоцианогени, mg/l90,591,391,893,4 Антиоксидантна активност - % инхибиране - екв. вит. С mmol/l 22,68 1428,37 22,58 1428,37 29,26 1755,26 35,74 2082,15
Хранително-вкусова промишленост 34
6/22 храни и
наука
актиоксидантна активност при ейл, обогатен с комбинация от амарант и ядливи цветя) са Табл. 4. Физико химични показатели на отлежало пиво ПоказателиКонтрола 20% амарант 20% амарант и 8,5 g/l невен 20% амарант и 8,5 g/l глухарче Начален
невена и 45,8% при глухарчето. Получените резултати (повишена
екстракт, масови %10,5310,5810,3510,58 Привиден екстракт, масови %1,692,613,552,97
очаквани предвид данните на Salanță et al. (2020), според които амарантът е сред суровините, които могат да подобрят антиоксидантната активност на специални пива. Влиянието на немалцуваните псевдо-зърнени култури има различни положителни аспекти, напр. –повлиява благоприятно аминокиселинния и мастнокиселинния профил (Bogdan et al., 2020). Цветята също допринасят значително за повишаване на полифенолното съдържание и радикал-улавящата способност на пивото поради антиоксидантните си свойства (Ivanov et al., 2018; Sabir et al., 2015). Глухарчето служи и като консервант на пивото (Josephson et al., 2016). Дегустационна оценка: Добра бистрота се наблюдава при контролата (100% ечемичен малц); останалите варианти са леко мътни (във връзка със замяна на част от ечемичния малц с амарант). Пивата са светли, добре охмелени, с хармоничен вкус. При вариантите, съдържащи ядливи цветя, се долавя тревист аромат. Josephson et al. (2016) също докладват за тревисти аромати, наподобяващи в някои случаи аромата на спанак, при добавяне на глухарче. Най-добра дегустационна оценка има пивото, обогатено с 20% амарант и глухарче. И З В О Д И ИЗВОДИ
1. Наличието на амарант и ядливи цветя в пивната мъст не води до смущения в развитието и размножаването на дрождите.
2. Обогатяването с растителни добавки подобрява усвояването на α-аминен азот от дрождите.
3. Горчивината на пивото не се влияе значително от наличието на растителни добавки.
4. Добавянето на псевдо-зърнена култура и ядливи цветя води до слабо повишаване на рН на готовото пиво.
5. Ядливите цветя са добър източник на полифеноли; при невена е отчетено 27,6% увеличение на този показател спрямо контролата, а при глухарчето – 38,8%. Замяната на 20% от ечемичния малц с амарант не води до повишено съдържание на полифеноли в пивото.
6. Съдържанието на флавоноиди в пивото не се повишава при обогатяването на мъстта с растителни добавки.
Fachverlag, Nürnberg.
3. Analytica Microbiologyca EBC (2001) Verlag Hans Carl Getränke-Fachverlag, Nürnberg.
4. Andrasofszky, E., Z. Szöcz, S. Fekete, K. Jelenits (1998) Evaluation of the nutritional value of the amaranth plant. I. Raw and heat-treated grain tested in experiments on growing rats. Acta Veterinaria Hungarica 46 (1) 47-59.
5. Arora, D., A. Rani, A. Sharma (2013) A review on phytochemistry and ethnopharmacological aspects of genus Calendula. Pharmacognosy Review 7 (14) 179-187.
6. Astafieva, A. A., E. A. Rogozhin, Y. A. Andreev, T. I. Odintsova, S. A. Kozlov, E. V. Grishin, T. A. Egorov (2013) A novel cysteine-rich antifungal peptide ToAMP4 from Taraxacum officinale Wigg. Flowers. Plant Physiology and Biochemistry 70, 93-99.
7. Bogdan, P.; E. Kordialik-Bogacka, A. Czyżowska, J. Oracz, D. Żyżelewicz (2020) The profiles of low molecular nitrogen compounds and fatty acids in wort and beer obtained with the addition of quinoa (Chenopodium quinoa willd.), amaranth (Amaranthus cruentus L.) or maltose syrup. Foods 9, 1626.
8. Caselato-Sousa, V. M., J. Amaya-Farfán (2012) State of knowledge on amaranth grain: a comprehensive review. Journal of Food Science 77 (4) R93-104.
9. Chakraborthy G. S., R. Arora, C. Majee (2011) Antidiabetic and antihyperlipaedemic effect of hydroalcoholic extract of Calendula officinalis. International Research Journal of Pharmacy 2, 61-65.
10. Choi, U. K., O. H. Lee, J. H. Yim, C. W. Cho, Y. K. Rhee, S. I. Lim, Y. C. Kim (2010) Hypolipidemic and antioxidant effects of dandelion (Taraxacum officinale) root and leaf on cholesterol-fed rabbits. International Journal of Molecular Sciences 11 (1) 67-78.
11. Das, S. (2016) Amaranthus: a promising crop of future. Springer Science + Business Media Singapore, DOI 10.1007/978-981-10-1469-7.
12. Deuschle, V. C. K. N., R. A. N. Deuschle, M. Piana, A. A. Boligon, M. R. B. Bortoluzzi, V. Dal Prá, C. B. Dolwisch, F. O. Lima, L. M. Carvalho, M. L. Athayde (2015) Phytochemical evaluation and in vitro antioxidant and photo-protective capacity of Calendula officinalis L. Leaves. Revista Brasileira de Plantas Medicinais Campinas 17 (4), supl. I, 693-701.
13. Díaz, K., L. Espinoza, A. Madrid, L. Pizarro, R. Chamy (2018) Isolation and identification of compounds from bioactive extracts of Taraxacum officinale Weber ex F. H. Wigg. (dandelion) as a potential source of antibacterial agents. Evidence-Based Complementary and Alternative Medicine, 2706417.
14. Domitrović, R., H. Jakovac, Z. Romić, D. Rahelić, Z. Tadić (2010) Antifibrotic activity of Taraxacum officinale root in carbon tetrachloride-induced liver damage in mice. Journal of Ethnopharmacology 130 (3) 569-577.
15. Eckhardt, F. (2008) Lager Beer vs. Ale Beer—Does It Matter?. All About Beer Magazine 29 (5).
16. Escudero, N. L., M. L. De Arellano, S. Fernández, G. Albarracín, S. Mucciarelli (2003) Taraxacum officinale as a food source. Plant Foods for Human Nutrition 58 (3) 1-10.
17. Fonseca, Y. M., C. D. Catini, F. T. M. C. Vicentini, A. Nomizo, R. F. Gerlach, M. J. V. Fonseca (2010) Protective effect of Calendula officinalis extract against UVB-induced oxidative stress in skin: evaluation of reduced glutathione levels and matrix metalloproteinase secretion. Journal of Ethnopharmacology 127 (3) 596-601.
18. Gallagher, E., T. R. Gormley, E. K. Arendt (2004) Recent advances in the formulation of gluten-free cerealbased products. Trends in Food Science & Technology (Review) 15 (3–4) 143-152.
19. Gomez, M. K., J. Singh, P. Acharya, G. K. Jayaprakasha, B. S. Patil (2018) Identification and quantification of phytochemicals, antioxidant activity, and bile acid-binding capacity of garnet stem dandelion (Taraxacum officinale). Journal of Food Science 83 (6) 1569-1578.
1. Alsoufi, A. S. M., C. Pączkowski, M. Długosz, A. Szakiel (2019) Influence of selected abiotic factors on triterpenoid biosynthesis and saponin secretion in marigold (Calendula officinalis L.) in vitro hairy root cultures. Molecules 24 (16) 2907.
2. Analytica EBC (1998) Verlag Hans Carl Getränke-
20. González-Castejón, M., B. García-Carrasco, R. Fernández-Dacosta, A. Dávalos, A. Rodriguez-Casado (2014) Reduction of adipogenesis and lipid accumulation by Taraxacum officinale (Dandelion) extracts in 3T3L1 adipocytes: an in vitro study. Phytotherаpy Research 28 (5) 745-752.
Хранително-вкусова промишленост 35
6/22 храни и наука
7.
8. Повишение на антиоксидантната активност, изразена като екв. вит. С mmol/l, се отчита при вариантите с цветя (22,9% при невена и 45,8% при глухарчето). За контакт с авторите: гл. ас. д-р Ива Томова, ст. експерт Албена Митрева, ст. експерт Йолина Дачева Институт по криобиология и хранителни технологии (ИКХТ), Селскостопанска академия, София 1407, бул. Черни връх
ЛИТЕРАТУРA
Слабо повишение на антоцианогените се отчита и при трите опитни варианта с добавки спрямо контролата.
53, tomova_iva@abv.bg; 0887547862
21. Grubben, G. J. H., O. A. Denton (eds) (2004) Plant resources of tropical Africa 2. Vegetables, PROTA Foundation, Wageningen, Netherlands / Backhuys Publishers, Leiden, Netherlands / CTA, Wageningen, Netherlands, pp. 668.
22. Ivanov, I. G. (2015) Polyphenols content and antioxidant activities of Taraxacum officinale F.H. Wigg (dandelion) leaves. International Journal of Pharmacognosy and Phytochemical Research 6 (4) 889-893.
23. Ivanov, I., N. Petkova, J. Tumbarski, I. Dincheva, I. Badjakov, P. Denev, A. Pavlov (2018) GC-MS characterization of n-hexane soluble fraction from dandelion (Taraxacum officinale Weber ex F.H.Wigg.) aerial parts and its antioxidant and antimicrobial properties. Zeitschrift für Naturforschung C. A Journal of Biosciences 73(1–2) 41-47.
24. Jiménez-Medina, E., A. Garcia-Lora, L. Paco, I. Algarra, A. Collado, F. Garrido (2006) A new extract of the plant Calendula officinalis produces a dual in vitro effect: cytotoxic anti-tumor activity and lymphocyte activation. BMC Cancer 6:119.
25. Josephson, M., R. Tockstein, A. Kleidon (2016) The Homebrewer‘s Almanac: A Seasonal Guide to Making Your Own Beer from Scratch. Countryman Press, New York, New York.
26. Kalvatchev, Z., R. Walder, D. Garzaro (1997) AntiHIV activity of extracts from Calendula officinalis flowers. Biomedicine & Pharmacotherapy 51 (4) 176-180.
27. Kasiram, K., P. R. Sakharkar, A. T. Patil (2000) Antifungal activity of Calendula officinalis. Indian Journal of Pharmaceutical Sciences 6, 464-466.
28. Kordialik-Bogacka, E.; P. Bogdan, K. PielechPrzybylska, D. Michałowska (2018) Suitability of Unmalted Quinoa for Beer Production. Journal of the Science of Food and Agriculture 98, 5027-5036.
29. Marcone, M. F., Y. Kakuda, R. Y. Yada (2003) Amaranth as a rich dietary source of beta-sitosterol and other phytosterols. Plant Foods for Human Nutrition 58 (3) 207-211.
30. Marinova, G., V. Batchvarov (2011) Evaluation of the methods for determination of the free radical scavenging activity by DPPH. Bulgarian Journal of Agricultural Science 17 (1) 11-24.
31. Martirosyan, D. M., L. A. Miroshnichenko, S. N. Kulakova, A. Pogojeva, V. I. Zoloedov (2007) Amaranth oil application for coronary heart disease and hypertension. Lipids in Health and Disease 6: 1.
32. Mishra, A. K., A. Mishra, A. Verma, P. Chattopadhyay (2012) Effects of Calendula essential oil-based cream on biochemical parameters of skin of albino rats against ultraviolet B radiation. Scientia Pharmaceutica 80 (3) 669683.
33. Montoya-Rodríguez, A., E. G. de Mejía, V. P. Dia, C. Reyes-Moreno, J. Milán-Carrillo (2014) Extrusion improved the anti-inflammatory effect of amaranth (Amaranthus hypochondriacus) hydrolysates in LPS-induced human THP1 macrophage-like and mouse RAW 264.7 macrophages by preventing activation of NF-κB signaling. Molеcular Nutrition and Food Research 58 (5) 1028-1041.
34. Moyer, T. B., L. R. Heil, C. L. Kirkpatrick, D. Goldfarb, W. A. Lefever, N. C. Parsley, A. J. Wommack, L. M. Hicks (2019) PepSAVI-MS Reveals a proline-rich antimicrobial Peptide in Amaranthus tricolor. Journal of Natural Products 82 (10) 2744-2753.
35. Murakami, T., A. Yutani, T. Yamano, H. Iyota, Y. Konishi (2014) Effects of popping on nutrient contents of amaranth seed. Plant Foods for Human Nutrition 69 (1) 25-29.
36. Naguib, N. Y., M. Y. Khalil, S. E. El Sherbeny (2005) A comparative study on the productivity and chemical constituents of various sources and species of Calendula plants as affected by two foliar fertilizers. Journal of Applied Sciences Research 1 (2) 176-189.
37. Niro, S., A. D’Agostino, A. Fratianni, L. Cinquanta, G. Panfili (2019) Gluten-free alternative grains: nutritional evaluation and bioactive compounds. Foods 8 (6) 208.
38. Pavsler, A., S. Buiatti (2009) Non-lager beer. In: Beer in health and disease prevention (Preedy, V.R., ed), Part 1, Chapter 2, 17-30, Elsevier, Ltd, Burlington, MA, USA, San Diego, CA, USA, London, UK.
39. Petri, G., G. Lemberkovics (1994) Instrumental analysis of medicinal plants and their drug products. Acta
Pharmaceutica Hungarica 64 (3) 87-93.
40. Pintea, А., C. Bele, S. Andrei, C. Socaciu (2003) HPLC analysis of carotenoids in four varieties of Calendula officinalis L. flowers. Acta Biologica Szegediensis 47 (1-4) 37-40.
41. Qazi, G., S. Ara, I. Murtaza, S. M. Geelani, H. Qazi (2016) Analysis of anthocyanins and carotenoids in two varieties of Calendula officinalis L. Flowers. International Journal of Agriculture, Environment and Biotechnology 9 (4) 545-554.
42. Ray, D., S. Mukherjee, M. Falchi, A. Bertelli, D. K. Das (2010) Amelioration of myocardial ischemic reperfusion injury with Calendula officinalis. Current Pharmaceutical Biotechnology 11 (8) 849-854.
43. Sabir, S. M., M. F. Khan, J. B. T. Rocha, A. A. Boligon, M. L. Athayde (2015) Phenolic profile, antioxidant activities and genotoxic evaluations of Calendula officinalis. Journal of Food Biochemistry 39 (3) 316-324.
44. Salanță, L. C., T. E. Coldea, M. V. Ignat, C. R. Pop, M. Tofană, E. Mudura, A. Borșa, A. Pasqualone, O. Anjos, H. Zhao (2020) Functionality of special beer processes and potential health benefits. Processes 8 (12) 1613.
45. Sarker, U., M. T. Islam, M. G. Rabbani, S. Oba (2018a) Variability in total antioxidant capacity, antioxidant leaf pigments and foliage yield of vegetable amaranth. Journal of Integrative Agricultural 17 (5) 1145-1153.
46. Sarker, U., M. T. Islam, M. G. Rabbani, S. Oba (2018b) Antioxidant leaf pigments and variability in vegetable amaranth. Genetika 50 (1) 209-220.
47. Sarker, U., M. T. Islam, M. G. Rabbani, S. Oba (2018c) Phenotypic divergence in vegetable amaranth for total antioxidant capacity, antioxidant profile, dietary fiber, nutritional and agronomic traits. Acta Agriculturae Scandinavica, Section B - Soil & Plant Science 68 (1) 67-76.
48. Sarker, U., T. Islam, G. Rabbani, S. Oba (2015) Genotype variability in composition of antioxidant vitamins and minerals in vegetable amaranth. Genetika 47 (1) 85-96.
49. Schneider, F., M. T. R. Danski, S. A. Vayego (2015) Usage of Calendula officinalis in the prevention and treatment of radiodermatitis: a randomized double-blind controlled clinical trial. Revista da Escola de Enfermagem da USP 49 (2) 220-226.
50. Schoenlechner, R., S. Siebenhandl, E. Berghofer (2008) Pseudocereals. In: Gluten-Free cereal products and beverages (Arendt, E. K., F. D. Bello, eds), London, San Diego: Elsevier, 149-176.
51. Silva-Sánchez, C., A. P. Barba de la Rosa, M. F. León-Galván, B. O. de Lumen, A. de León-Rodríguez, E. González de Mejía (2008) Bioactive peptides in amaranth (Amaranthus hypochondriacus) seed. Journal of Agricultural and Food Chemistry 56 (4) 1233-1240.
52. Srividya, A. R., P. H. Balaji, H. Raghu, P. Vijayan (2008) Antioxidant and anti-adipogenic activity of Taraxacum officinale by in vitro screening methods. The Pharmacist 3 (1) 41-44.
53. Sweeney, B., M. Vora, C. Ulbricht, E. Basch (2005) Evidence-based systematic review of dandelion (Taraxacum officinale) by natural standard research collaboration. Journal of Herbal Pharmacotherapy 5 (1) 79-93.
54. Tumbarski, Y., N. Petkova, I. Ivanov (2016) Polyphenolic content, antioxidant activity and antimicrobial properties of leaf extracts from dandelion (Taraxacum officinale). Industrial technologies, vol. III (1) 141-145.
55. Venskutonis, P. R., P. Kraujalis (2013) Nutritional components of amaranth seeds and vegetables: a review on composition, properties, and uses. Comprehensive Reviews in Food Science and Food Safety 12 (4) 381-412.
56. Weerasekara, A. C., V. Y. Waisundara (2020) Amaranth as a pseudocereal in modern times: nutrients, taxonomy, morphology and cultivation. In: Nutritional Value of Amaranth, DOI: 10.5772/intechopen.90927.
57. Wirngo, F. E., M. N. Lambert, P. B. Jeppesen (2016) The physiological effects of dandelion (Taraxacum officinale) in type 2 diabetes. The Review of Diabetic Studies 13 (2-3) 113–131.
58. Xiong, H., Y. Cheng, X. Zhang, X. Zhang (2014) Effects of taraxasterol on iNOS and COX-2 expression in LPS-induced RAW 264.7 macrophages. Journal of Ethnopharmacology 155 (1) 753-757.
Хранително-вкусова промишленост 36 6/22 храни и наука
Р е з ю м е Резюме Изследванията относно получаването, свойствата и приложението на кисела и алкална електролизна вода датират отдавна, но в последните две десетилетия се наблюдава все по-широко разпространение на различни апарати за електролиза на водата, както и натрупване на нови знания за потенциала и възможните ѝ приложения. Алкалната електролизна вода се отличава с високо рН (10 до 13), отрицателен окислително-редукционен потенциал (−800 до −900 mV), голямо съдържание на разтворен водород и мощен антиоксидантен ефект. Киселата електролизна вода е с ниско рН (2,3 до 2,7), голям окислително-редукционен потенциал (над 1 000 mV), висока концентрация на разтворен кислород, съдържа активен хлор. Освен това от апаратите за електролиза на водата се получава и по-слабо алкална вода (рН 8,5 до 9,5), и по-слабо кисела вода (рН 4 до 6). Съответно и окислително-редукционният потенциал (ОРП) е с по-малки абсолютни стойности. Приложението на алкалната електролизна вода в хранително-вкусовата промишленост (ХВП) към момента е изследвано сравнително слабо. Поради своето мощно антиоксидантно действие и алкален характер нейната употреба се свързва предимно със здравословни ползи, потвърдени в редица научни публикации. Високата алкалност на тази вода я прави потенциален агент за почистване на органични замърсявания от различни
Electrolysis of water –possible applications in the food industry
Part 1. Application of alkaline electrolyzed water Review
Assoc. Prof. Maria Kaneva, PhD University of Food Technologies – Plovdiv, Department of Wine and Beer Technology m_kaneva@uft-plovdiv.bg
A b s t ra c t Abstract
The studies on the production, properties and application of acidic and alkaline electrolyzed water have been done for a long time, but in the last two decades, there is a large dissemination of different appliances for water electrolysis, as well as a gathering of new knowledge about its application. The alkaline electrolyzed water has a high pH value (10–13), negative ORP (–800 to –900 mV), a high content of dissolved hydrogen and a strong antioxidant activity. The acidic electrolyzed water has a low pH value (2.3–2.7), a high ORP (>1000 mV), a high content of dissolved oxygen and free chlorine. Furthermore, less alkaline (pH 8.5–9.5) and less acidic (pH 4–5) water can be produced by appliances for electrolysis of water. Accordingly, the ORP value is lower, too.The application of alkaline electrolyzed water is a little bit studied at the moment. Because of its strong antioxidant properties and alkaline character, its application has been manly connecting with health positive aspects. Due to the high pH value this water can be used to clean organic pollutants from different surfaces. It is a good emulsifier of fats. Probably, the extremely high pH and ORP values could suppress grow of many microorganisms, but there is no enough information about such investigations.
The application of alkaline electrolyzed water in the food industry has been studied relatively poorly to date. Because of its strong antioxidant activity and alkaline character, its application has been mainly related to health
Хранително-вкусова промишленост 37
6/22 храни и наука
повърхности.
добри емулгиращи свойства спрямо
екстремно високите стойности на рН и ОРП могат да са лимитиращи за развитието на редица микроорганизми, но към момента липсва достатъчно информация за подобни изследвания. Ключови думи: алкална и кисела електролизна вода, приложение в ХВП.
Тя проявява и много
мазнините. Вероятно
Електролиза на водата –възможности за приложение в хранително-вкусовата промишленост Част 1. Приложение на алкална електролизна вода Обзор доц. д-р Мария Кънева
benefits, while a number of scientific publications confirm these benefits. Due to the high pH value, this water can be used to clean organic pollutants from different surfaces. It is also a good emulsifier of fats. Probably, the extremely high pH and ORP values could suppress the growth of many microorganisms, but there is no enough information about such investigations.
Key words: alkaline and acidic electrolyzed water, application in food industry В ъ в е д е н и е Въведение Електролизата на водата е позната на хората отдавна. Това е процес при който водата се разлага на водород и кислород под действие на електрически ток, протичащ между два електрода (анод и катод), потопени във водата. Електролизата на химически чиста вода е доста труден процес. Наличието на соли във водата реално подобрява нейната електропроводимост, което от своя страна увеличава ефективността на електролизата. През последните две десетилетия има значителен интерес и множество изследвания, свързани с разработването на апарати за електролиза и получаване на два типа вода, чрез разделянето ѝ в областта около катода от тази около анода, както и изследване на свойствата на различните типове вода. Апаратите за електролиза на водата много често се наричат йонизатори, електролизери или генератори на електролизна вода, а двата типа вода, които се получават се наименуват с най-различни термини. Водата, която се формира около катода бива означавана като: 1) електрохимически възстановена вода (electrochemically reduced water); 2) електролизно възстановена вода (electrolyzed reduced water); 3) алкална електролизна вода (basic electrolyzed water) 4) йонизирана алкална вода (ionized alkaline water) или само алкална вода; 5) католит; 6) жива вода. Водата, която се формира около анода бива назовавана като: 1) електрохимически окислена вода (electrochemically oxidizing water); 2) електролизно окислена вода (electrolyzed oxidizing water); 3) кисела електролизна вода (acidic electrolyzed water); 4) йонизирана кисела вода (ionized acidic water) или само кисела вода; 5) анолит; 6) мъртва вода. Изследвания за свойствата на електрохимически възстановената вода са инициирани в Япония през 1931 година, а през 1966 година японското министерство на здравето, труда и благосъстоянието признава тази вода като ефективна при хронична диария, лошо храносмилане, ненормална стомашно-чревна ферментация, хиперацидност и разрешава производството на устройства за домашна употреба, с които да се получава електрохимически възстановена вода (Sanetaka et al., 2012). В днешно време тези устройства са признати за медицински изделия в Япония, Русия и Германия (Ашбах, 2017). Има редица медицински изследвания, които разглеждат влиянието на електрохимически възстановената вода при различни заболявания (Sanetaka et al., 2012). Генераторите на електролизна вода са официално признати за приложение в хранителната индустрия от Агенцията за защита на природата в САЩ (Park et al., 2002, чрез Yu-Ru Huang et al., 2008). В редица страни, включително и в България, се предлага голямо разнообразие от устройства за елек-
тролиза на вода за домашно ползване. В България тези устройства са познати под наименованието йонизатори за вода. За тяхното захранване се използва питейна вода от водопроводната система. Освен електролиза на водата, тези устройства в повечето случаи съдържат и филтрираща система в която са включени както активен въглен, така и други материали, които осигуряват дълбочинно пречистване на водата от редица примеси. В повечето случаи йонизаторите са проточни, но има и стационарни. В йонизаторите за домашна употреба, йонизирането на водата или поточно нейното дисоцииране на хидроксилен катион и водороден анион се постига или чрез електролиза, или чрез минерали като турмалин и корал. Използването на електролиза има много по-добър ефект в сравнение с минералите. Системите за електролиза на вода с цел приложение в ХВП се различават от тези за домашна употреба по своя капацитет, както и по-това, че към захранващата вода се добавя натриев хлорид. В някои от системите за домашна употреба също има възможност за добавяне на електролитни разтвори, с които да се увеличи ефективността на електролизата. В настоящата статия ще бъдат разгледани възможностите за приложение на различните типове вода, получавани от системите за електролиза на водата в ХВП. С оглед улесняване на изложението, водата получавана около катода ще бъде обозначавана като алкална електролизна вода, а тази получавана около анода с кисела електролизна вода. Механизъм на получаване и свойства на вода та обработена чрез електролиза За да се изяснят свойствата на алкалната и кисела електролизна вода е необходимо да се познава процесът електролиза и реакциите, които протичат в електролизната клетка (фиг.1). Когато във водата се потопят два електрода (анод и катод), които са свързани към източник на електричество, се получава затворена електрическа верига, тъй като водата има свойството да провежда електрически ток. Това свойство нараства с увеличаване количеството на разтворените във водата соли. Под действие на електрическия ток водата се дисоциира на водороден йон (Н+) и хидроксилен йон (ОН¯). 2H₂O → 4H⁺ + 2OH⁻ (1) Водородните йони се привличат от отрицателно заредения електрод (катод), където се възстановяват (редуцират) до атомен водород (Н), приемайки електрони от катода. Атомният водород е нестабилен, поради което много бързо
храни и наука 38 3/22 храни и наука
Хранително-вкусова промишленост 38 6/22
два атома водород се свързват и образуват молекулен водород (Н2) под формата на газ. На катода винаги се получава редукция (възстановяване), тъй като реакциите които протичат там са свързани с приемане на електрони. 4H₂O + 4e- → 2H₂(газ) + 4OH (2) Хидроксилните йони се привличат от положително заредения електрод (анод), където отдават електрони и се окисляват образувайки кислород под формата на газ (О2), както и водородни йони (Н+). На анода винаги се получава окисление, тъй като реакциите които протичат там са свързани с отдаване на електрони.
2H₂O → 4H⁺ + O₂ (газ) + 4e (3) Двете реакции, които протичат на анода и катода са половината от една обща окислително-редукционна реакция. Ако се направят съответните съкращения от двете страни на уравнения (2) и (3) ще се получи уравнение (1). Както се вижда от реакциите (2) и (3) на анода се получава водороден йон (Н+), а на катода хидроксилен йон (ОН¯), т.е. в близост до анода се формира киселина, а в близост до катода равна по концентрация основа. Ако водата около катода се смесва с тази около анода няма да има промяна в рН на водата, но ако се постави мембрана, която да разделя водата около катода с тази около анода ще се формира алкална вода около катода и кисела вода около анода. Солите, които се съдържат във водата също се дисоциират на катиони и аниони, поради което анодът привлича не само хидроксилните аниони, но и всички аниони на разтворените соли, а катодът привлича не само водородните катиони, но и катионите на солите (фиг.1). (Yu-Ru Huang et al., 2008; MHI, 2022)
Когато във водата се добави натриев хлорид, хлорният йон се окислява преимуществено на анода (уравнение 4). В киселата електролизна вода се формира газообразен хлор, който реагира с водата и се получава хипохлориста киселина и разредена солна кисели-
на (уравнение 5). 2NaCl → Cl₂ + 2Na + 2e- (4) H₂O + Cl₂ → HOCl + HCl (5) На катода се образува разредена натриева основа. 2NaCl + 2OH¯ → 2NaOH + 2Cl¯ (6) Същият ефект се получава ако се прибави KCl, Ca(Cl)2 или друга сол, съдържаща хлорид. Обикновената водопроводна вода също съдържа хлориди и този ефект се получава, но в по-малка степен, тъй като концентрацията на хлоридите в питейните води е сравнително малка.(Yu-Ru Huang et al., 2008; MHI, 2022). Освен тези реакции, според Al -Haq et al., 2005, на анода се формира хидроксилен радикал, който образува водороден пероксид. H₂O → H⁺ + ·ОН + e (7) ·ОН + ·ОН → H₂O₂ (8) Както бе споменато по-горе на катода протичат редукционни (възстановителни) реакции свързани с приемане на електрони от катода. Това води до получаване на отрицателен ОРП, докато на анода се формира силно положителен ОРП, тъй като протичат окислителни реакции, свързани с отдаване на електрони към анода. Обобщавайки написаното до тук от системите за електролиза на водата се получават два потока: 1) кисела електролизна вода, която се получава в зоната около анода – с ниско рН (2,3 – 2,7), голям ОРП (над 1°000 mV), значително съдържание на разтворен кислород, съдържаща свободен хлор; 2) алкална електролизна вода, която се получава около катода – с високо рН (10 – 13), отрицателен ОРП (−800 до −900 mV) и голямо съдържание на разтворен водород (Yu-Ru Huang et al., 2008, Hricova et al., 2008).

Когато водопроводната вода е единственият източник на йони, системата за електролиза произвежда „леко“ алкална вода с pH (8 – 11) и отрицателен OРП (−50 до −750 mV) на катода, и „леко“ кисела вода с pH (4 – 6) и положителен OРП (+350 до + 750 mV) на анода. Тези стойности много зависят от апарата, pH и съдържанието на йони/ минерали във водопроводната вода, (MHI, 2022), както и от дебита на водата при проточните йонизатори (Ашбах, 2017, Yu-Ru Huang et al., 2008). Понятията „леко“ алкална и „леко“ кисела електролизна вода не са строго дефинирани. Стойностите на рН
Хранително-вкусова промишленост
6/22 храни и наука
39
в
Tap water –Salt solution –Amperage –Electrolyzed oxidaizing water –Electrolyzed reduced water –Dilute–MembraneGasФиг. 1 Схема на електролизна клетка
и ОРП
различните публикации варират в доста големи диапазони.
Стабилността на рН и ОРП на киселата и алкалната електролизна вода, както и концентрацията на свободен хлор в киселата електролизна водата са различни и се променят с времето. Изследвания в тази посока са извършени от Khalid et al., 2021. Активната киселинност (рН) е най-устойчивият показател. Тя се запазва без промяна както в киселата, така и в алкалната електролизна вода, в продължение на седемдневно съхранение в тъмнокафяви, добре затворени бутилки при стайна температура (25 – 30°С). Окислително-редукционният потенциал на киселата електролизна вода се запазва в рамките на пет дни, след което се наблюдава тенденция към намаляване. Докато ОРП на алкалната електролизна вода бележи значително намаление още между първия и втория ден от съхранението. След третия ден, ОРП на алкалната електролизна вода се запазва сравнително постоянен, но вече има положителна стойност. В деня на получаване на киселата електролизна вода, тя съдържа по10 mg/L свободен хлор, общ хлор и водороден пероксид, но по време на съхранението тяхната концентрация намалява непрекъснато, като на седмия ден не се открива нито хлор, нито водороден пероксид (Khalid et al., 2021). Тези резултати показват, че ефективността на киселата и особено на алкалната електролизна вода намаляват с времето, което означава, че те трябва да се получават непосредствено преди използване. В последните две десетилетия има редица научни публикации, които потвърждават антимикробното действие на киселата електролизна водата и съобщават за много добри резултати при обработка на плодове, зеленчуци, месо, животински продукти, риба, морски дарове, както и при третиране на различни повърхности с цел дезинфекция (Athayde et al.,2018; Pianpian Yan et al., 2021; Yu-Ru Huang et al., 2008). Прилагането на киселата електролизна водата като дезинфектант в ХВП се лансира като ефективен, икономически поизгоден, щадящ околната среда и хората метод. Пообстоен преглед на наличната към момента информация, свързана с възможностите, които киселата електролизна вода предлага ще бъде направен във втората част
лен когато водата се съхранява (Ашбах, 2017). В научната литература има редица медицински изследвания свързани с въздействието на алкалната електролизна вода върху редица заболявания. Натрупаните доказателства показват, че тя е полезна за здравето и потиска заболявания, свързани с оксидативния стрес, като диабет, рак, атеросклероза, невродегенеративни заболявания и страничните ефекти на хемодиализата (Sanetaka et al., 2012). Известно е, че механизмите за действие на антиоксидантите се основават или на пренос на водород или на пренос на електрони. Това са тъй наречените SET (single electron transfer) и HAT (hydrogen atom transfer) механизми. Отрицателната стойност на ОРП на алкалната електролизна вода означава, че тя има излишък на електрони. Отдавайки своите свободни електрони на различни радикали, тя ги обезврежда, превръщайки ги в неутрални молекули. Предимството на алкалната електролизна вода пред другите антиоксиданти се дължи на това, че след като отдаде своите електрони на свободните радикали тя не се превръща в свободен радикал, а в неутрална молекула вода (Ашбах, 2017). Алкалната електролизна вода има свойството да обезврежда реактивни кислородни частици. Според Sanetaka et al., 2012 механизмите на обезвреждане са сложни, като в тях участват различни елементи, присъстващи в алкалната електролизна вода. Съдържащият се в нея атомен водород има силен редуциращ (възстановяващ, антиоксидантен) ефект. Той бързо се превръща в молекулен водород, който е с по-слабо редукционно действие, но пък може да е източник на атомен водород. Освен това в алкалната електролизна вода се съдържат минерални наночастици и техни хидриди. Sanetaka et al., 2012 считат, че те имат съществена роля при формирането на антиоксидантните свойства на алкалната електролизна водата. Според тях минералните наночастици поддържат редукционна среда, тъй като постепенно се дисоциират на йони, отделяйки електрони. Освен това, чрез каталитични механизми директно обезвреждат . В допълнение стимулират отделянето на водородни атоми от редица органични молекули като антиоксиданти и метанол, а хидридите на минералните наночастици могат да освобождават водородни атоми. Според Sanetaka et al., 2012 тези механизми за обезвреждане на реактивни кислородни частици обясняват специ-
Hita Tenryosui в Япония и Nordenau в Германия (Sanetaka et al., 2012, Ашбах, 2017), Красновските минерални бани в България. Техният отрицателен ОРП бързо намалява и дори може да стане положите-
Хранително-вкусова промишленост 40
6/22 храни
и наука
на статията. Приложение на алкалната електролизна вода В масовите информационни източници много интензивно се изтъкват здравословните ползи от консумацията на алкална електролизна вода. В тези източници тя се нарича жива вода, алкална йонизирана вода или много често просто алкална вода, като здравословните ползи от нейната консумация се свързват предимно с това, че водата е алкална. Подобни твърдения всъщност са непълни и понякога водят до заблуждения. Важно е да се отбележи, че има природни алкални води, чието рН е в диапазона 8,5 – 9,5. България е богата на такива води. Голяма част от нашите найизвестни извори на натурална минерална вода, която се бутилира и предлага за питейни цели, са именно такива алкални води. Малко са обаче природните води със силно намален или отрицателен ОРП. Такива са изворите
фичните свойства както на алкалната електролизна вода, така и на природни води които имат редуктивен характер (отрицателен или много малък положителен ОРП). Авторите изказват предположение, че алкалната електролизна вода може да подпомогне ХВП чрез подобряване на вкуса, текстурата и консервирането на храните. Високото рН на алкалната електролизна вода и образуването на основа при добавяне на електролити от рода на NaCl, KCl, CaCl2 в процеса на нейното получаване ѝ придават свойства подобни на алкално действащите препарати за почистване. Това я прави подходяща за почистване на замърсявания и на мазнини от различни повърхности. Подобно приложение се лансира и от Yu-Ru Huang et al., 2008. От друга страна стойности на рН от порядъка на 10 – 13 вероятно са лимитиращи за развитието на определени микроор
ганизми и може да се предполага, че силно алкалната електролизна вода има антимикробни свойства, но към момента липсва достъпна информация за подобни изследвания. В определени публикации се съобщава, че обработката на различни хранителни продукти с алкална електролизна вода преди третирането им с кисела електролизна вода увеличава антимикробния ефект спрямо обработка само с кисела електролизна вода (Hricova et al., 2008). З а к л ю ч е н и е Заключение Оскъдните научни данни за влиянието на алкалната електролизна вода и възможните ѝ приложения в ХВП дават широко поле за изследователска работа чрез която да се търсят отговори както на научни въпроси за механизмите на действие, така и на практически въпроси за приложението на тази вода в ХВП, медицината и бита. Наличните към момента медицински изследвания и познанието, относно действието на алкалната електролизна вода като мощен антиоксидант, могат да послужат като добра основа и катализатор за бъдещи разработки.
За контакти с автора: доц. д-р Мария Кънева Университет по хранителни технологии – Пловдив катедра „Технология на виното и пивото“ m_kaneva@uft-plovdiv.bg
Литература

1. Ашбах, Д. (2017) Живата и мъртвата вода срещу окисляването и стареенето. Издателство Перитет, София, ISBN 978-619-153-050-2.
2. Al-Haq, M.I., J.Sugiyama, S. Isobe (2005) Applications of Electrolyzed Water in Agriculture and Food Industries. Food Science and Technology Research 11 (2) 135-150. https://doi.org/10.3136/fstr.11.135
3. Hricova, D., R. Stephan, C. Zweifel (2008) Electrolyzed water and its application in the food industry. Journal of Food protection 71 (9) 1934-1947.
4. Khalid, N.I., N. S. Sulaiman, N. Ab Aziz, F.S. Taip, S. Sobri, M.A.R. Nor-Khaizura (2021) Stability of electrolyzed water: from the perspective of food industry. Food Research 5 (Suppl. 1) 47-56. https://doi.org/10.26656/fr.2017.5(S1).027
5. MHI, (2022) Molecular Hydrygen Institute. http://www. molecularhydrogeninstitute.com/electrolysis достъп май, 2022




6. Park, H., Y. C. Hung, C. Kim (2002) Effectiveness of electrolyzed water as a sanitizer for treating different surfaces. Journal of Food Protection 65 1276-1280.
7. Shirahata S., T. Hamasaki, K. Teruya (2012) Advanced research on the health benefit of reduced water. Trends in Food Science & Technology 23 (2) 124-131. https://doi. org/10.1016/j.tifs.2011.10.009
8. Yu-RuHuang, Yen-ConHung, Shun-YaoHsu, Yao-WenHuang, Deng-FwuHwang (2008) Application of electrolyzed water in the food industry. Food Control 19 (4) 329-345. https://doi.org/10.1016/j.foodcont.2007.08.012
тика, патентна защита и др... Федерацията на научно-техническите съюзи ще ви осигури конферентни и изложбени зали, симултанна техника, отлични възможности за провеждане на вашите събития, промоции, коктейли. Спестете време, средства
Хранително-вкусова промишленост 41
6/22 храни и наука
Цените са без ДДС и са в сила от 01. 01. 2019 г. ! З а л а № 3 Зала №3 ФНТС ВИ ПРЕДЛАГА КОМПЛЕКСНИ УСЛУГИ: Специалисти-консултанти за разработване на проекти, свързани с технологични иновации,
поли-
и енергия като се възползвате от комплексните услуги на Федерацията и удобните зали от 14 до 250 места, в центъра на София. ЗАПОВЯДАЙТЕ ПРИ НАС! София, 1000 , ул. „Г. С. Раковски” №108 Национален дом на науката и техниката, тел: 02/ 987 72 30 БЕЗПЛАТНО, факс: 02/ 987 93 60 Делнични дни Зала, брой места до 2 часа до 4 часа над 4 часа до 4 часа над 4 часа Зала №1 (85 кв. м)119 лв.225 лв.310 лв.275 лв.390 лв. Зала №2 (40 места)119 лв.215 лв.295 лв.265 лв.340 лв. Зала №3 (90 места) 190 лв.285 лв.360 лв.360 лв.425 лв. Зала №4
Зала №105 А
Зала №10869
Зала №109 (до 27 места) 85 лв.105
Зала №302 (14 места/ 65 лв.89
Зала №312 (до 25 места) 85 лв.105
Зала №315 (14 места)
Зала №507 (20 места) 72 лв.95
З а л а № 4 Зала №4
финансова
(250 места)395 лв.495 лв.495 лв.595 лв.
(54 места) 109 лв.200 лв.295 лв.255 лв.340 лв.
лв.89 лв.105 лв.135 лв.
лв.140 лв.140 лв.190 лв.
лв.120 лв.120 лв.165 лв.
лв.140 лв.140 лв.190 лв.
69 лв.89 лв.105 лв.135 лв.
лв.130 лв.130 лв.175 лв.
Pop & Bottle е компания за кафе, основана от жени. Тя е известна с първокласни, органични, безмлечни, овесени кафета и лате с бадемово мляко. Сега компанията разширява предложенията си с линия суперконцентрати. Трите продукта – класическо студено варено кафе, ванилово студено варено кафе и мока студено варено кафе се предлагат изключително в магазините на Уолмарт и онлайн. „Произведен от специални зърна арабика, директно доставяни от Централна Америка, този вкусен концентрат за кафе позволява само с една супена лъжица да приготвите всяка любима кафена напитка у дома с лекота – без да е необходима френска преса, машина за шварц кафе или за еспресо“, обясняват от основаната през 2015 г. и базирана в Лос Анджелис компания: Патентованият устойчив процес на екстракция на Pop & Bottle позволява извлечане на 90% от кафето на всяко зърно с минимални отпадъци и значително намалено окисляване, в резултат на което се получава изключителен, 15 пъти по-силен, кафе концентрат със силен аромат.


Притежаваното от PepsiCo предприятие Quaker Oats анонсира дебюта на своята нова гама каша с ниско съдържание на мазнини, сол и захар, наречена Heavenly Oats.

на потребителите. Нови линии кефир, полезни за здравето
кефирени напитКаши с ниско съдържание на мазнини, сол и захар Суперконцентрати за кафе
йогурти и овесени на-
42 6/22 новости
Biotiful Dairy анонсира дебюта на своите нови продуктови линии кефир Biotiful Gut Health, осигуряващи подкрепа за имунната система
Новите артикули включват
ки, йогурти, протеинови
питки на
Изделията се предлагат в два варианта: шоколад и портокал, богат на какао и с флейки тъмен шоколад, както и карамелен фъдж с „лепкави“ парченца фъдж. Хийтър Дойл, главен бранд мениджър в Quaker, споделя: Със завръщането на хората по офисите важността на удобството при храненето нараства. Потребителите търсят по-здравословни закуски, предлагащи разнообразни вкусове. Линията Heavenly Oats на Quaker е перфектното решение, тъй като предлага богат вкус в идеалната порция каша. всеки предлаган в разфасовка от 500 милилитра. Предлагането на изделията се очаква да стартира през септември чрез водещите британски супермаркети.
растителна основа. Напитките Gut Health Kefir Drinks се предла-
гат в семейни опаковки от 1 литър във варианти оригинал и ванилия и ягода. От своя страна изделията Kefir Yogurts дебютират с вкусове британска ягода, мадагаскарска ванилия, вишна морело и Руби малина. Тази линия е съпътствана от гамата протеинови млека на Biotiful – представени от вариантите Ванилия и Шоко-лайт, – като двете групи продукти са идеални за здравословна закуска или десерт за потребители от всички възрастови групи. А артикулите Plant-Based Oat Kefir Drinks са лансирани като „първите на пазара“ култивирани напитки на основата на овес, ферментирали с живи веган кефирни култури и с добавени калций и витамини B12 и D. Новите варианти тук включват ванилия, ягода и оригинален,
627379; 601870, e-mail: thi@mbox.contact.bg; sales@thermohran.com; www.thermohran.com




















Внос и продажба на консумативи за месната индустрия. Форми за шунки. Витрини за зреене на месо и колбаси.




М и л м е к с О ОД Милмекс ООД


Производство на захарни и шоколадови изделия, диетични и диабетични продукти
2227 Божурище бул. Европа 156 тел.: 02 993 2900 факс: 02 993 3225 e-mail: milmex@mail.bg; info@milmex.eu www.milmex.eu


EООД „Д-р Грозева - АРОМСА”
Индустриална
факс:


УХТ, Пловдив Катедра „Биотехнология” разполага със съвременна апаратура за извършване на:


Микробиологични

43 6/22 www.intrama-bg.com 9354 Дончево, обл. Добрич, тел.: 058 625534, 626612, факс: 058 622766 e-mail: zora@netplusdb.bg www.zora-donchevobg.com Производство, преработка и търговия на яйца, пилета и птичи продукти 1000 София Магазин: ул. Гургулят 27, Цех: ул. Орчо Войвода 8 Б Тел.: 02/ 952 26 25, 955 62 20 Факс: 02/955 63 05 е-mail: salon@mb.bia-bg.com web: bg-salon.com САЛОН ЕООД Производство на хлебни и сладкарски изделия, локуми, халва, филиран бадем, филиран фъстък, фондан. бизнессправочник “ П И Л К О ” Е О О Д “ПИЛ КО” ЕО ОД Производство и преработка на птиче месо
èíæåíåðèíã ® 6000 Стара Загора, ул. Христо Ботев 117 А, Тел: 042 622 201;
Машини и технологични линии за консервната промишленост. Топлообменници и изпарителни инсталации за всички отрасли. Захарни Заводи АД е найголемия комплекс в България за производство на захар, захарни изделия, спирт и опаковки. гр. Горна Оряховица ул. “Свети Княз Борис I” 29 тел.: 0618/69500 факс: 0618/21709 e-mail:office@zaharnizavodi.com ТЕА ТРЕЙДИНГ ООД
7200 София, кв. Горубляне, ул.
Разград,
зона, П.К. 181 тел.: 084/ 66 10 86; 66 10 87
084/ 66 10 92 e-mail: pilko@mbox.digsis.bg
анализи на суровини, храни, напитки, фуражи и др.
Биохимични и химични анализи на суровини, храни, напитки, фуражи и др. (микотоксини и други замърсители в храните); Качествено и количествено определяне на ГМО в растителни и животински суровини и хранителни продукти. За контакти: ректор: тел.: +359 32 643 005 факс: +359 32 644 102 rector_uft@uft-plovdiv.bg http://www.uft-plovdiv.bg
1138
Люляк 9 тел/факс: 02 974 50 01, 02 974 50 28 моб.: 088 8915 249, 088 7989 830 e-mail: teatrading@abv.bg, www.teatrading.eu
ЕООД
Производство на захарни изделия от ориенталски тип: халви – нуга, карамелена, слънчогледова, сусамова, бяла халва; локум роза, локум с добавки – с орехи, с бадеми, със смокини; локум със сини сливи, локум с червени боровинки; локум виолетка; различни видове тахани –слънчогледов, сусамов бял, сусамов пълнозърнест, фъстъчен. гр. Бургас, кв. “Акации”, ул. “Горазд” 16 тел.: 056 / 84 26 84 e-mail: bul_tat@mail.bg
“ЗЕНА” ООД
Пълна гама санитарни помпи от неръждаема стомана, устройства за обливане и миене, бъркалки. Пълна гама арматура и принадлежности от неръждаема стомана. Пластмасови блок форми за сирене. Хомогенизатори и сепаратори.
6300 Хасково, пл. Общински 5 тел./факс: 038/ 626 042 склад тел.: 038/ 620 256 e-mail: zena@zena-bg.com; www.zena-bg.com












“Градус-1”
ООД
месо и пилешки продукти, разплодни яйца, еднодневни пилета. Богата гама охладени и замразени птичи продукти, полуфабрикати, деликатеси и колбаси.

6000 Стара Загора, кв. Индустриален, П.К. 285; Тел.: 042 617101; e-mail: gradus@gradusbg.com
Производство на месни кулинарни заготовки – порционирани, замразени, готови за директно влагане, с насоченост конвектомати, скари и фритюри в търговски вериги. ISO 9001:2008.
ул. “Лиляна Ставрева” 8, Произв. база: бул. “Хр. Смирненски”
44 6/22 бизнессправочник
№ 33, тел.:
479; 511 480; тел/факс:052/511 437 “РАДУЛОВ” ЕООД Газирани, негазирани напитки 6010 Стара Загора Индустриален квартал тел.: 042/ 60 47 46, факс: 042/ 63 84 23 e-mail: radulov@mail.orbitel.bg www.radulov-bg.com София 1463, бул. България 81, вх. А, ет. 8, оф. 11 тел.: 02 953 24 21, 02 952 66 56, 02 952 03 76 факс: 02 953 24 28 e-mail: office@bulgarconserv07.com www.bulgarconserv07.com Булгарконсерв Рупите К о н с е р в и р а н и Консервирани з е л е н ч у ц и . зеленчуци. К о м п о т и Компоти гр. Троян,
ул. Ген.
факс:
e-mail:
тел.
моб. тел.:
Хлебопроизводство и сладкарство ЕООДТроян Производство на хляб и хлебни изделия, козунаци, погачи, дюнерпитки Генерал Тошево 9500, ул. Св. св. Кирил и Методий 1, тел. 057312485 e-mail:
ДОБРУДЖА ООД ПРОИЗВОДСТВО НА ХЛЯБ И ТЕСТЕНИ ИЗДЕЛИЯ 1510 София жк. Хаджи Димитър тел: 02/ 936 72 25, 936 78 06 e-mail: aea_company@yahoo.com www.aeabg.com А Е А АЕА Производство на сладкарски изделия
Варна,
052/511
п.к.5600
Карцов №387
0670 62518
troyahleb@abv.bg
за заявки: 0670 62762
0884 851 478
alisa_gt@abv.bg
на
Производство
пилешко
1784 София, бул. “Йерусалим” 54 тел.: 02 974 05 48, факс: 02 974 08 17 е-mail:
ДАТРА БЪЛГАРИЯ ЕООД Д Представител на европейски фирми, произвеждащи машини и съоръжения за хранителната промишленост
office@datrabg.com, www.datrabg.com

















































+359 87 652 0442 +359 02 400 5000 sales@voo-doo.eu www.voo-doo.eu » Опаковки » Етикети » Промо кутии » Брошури